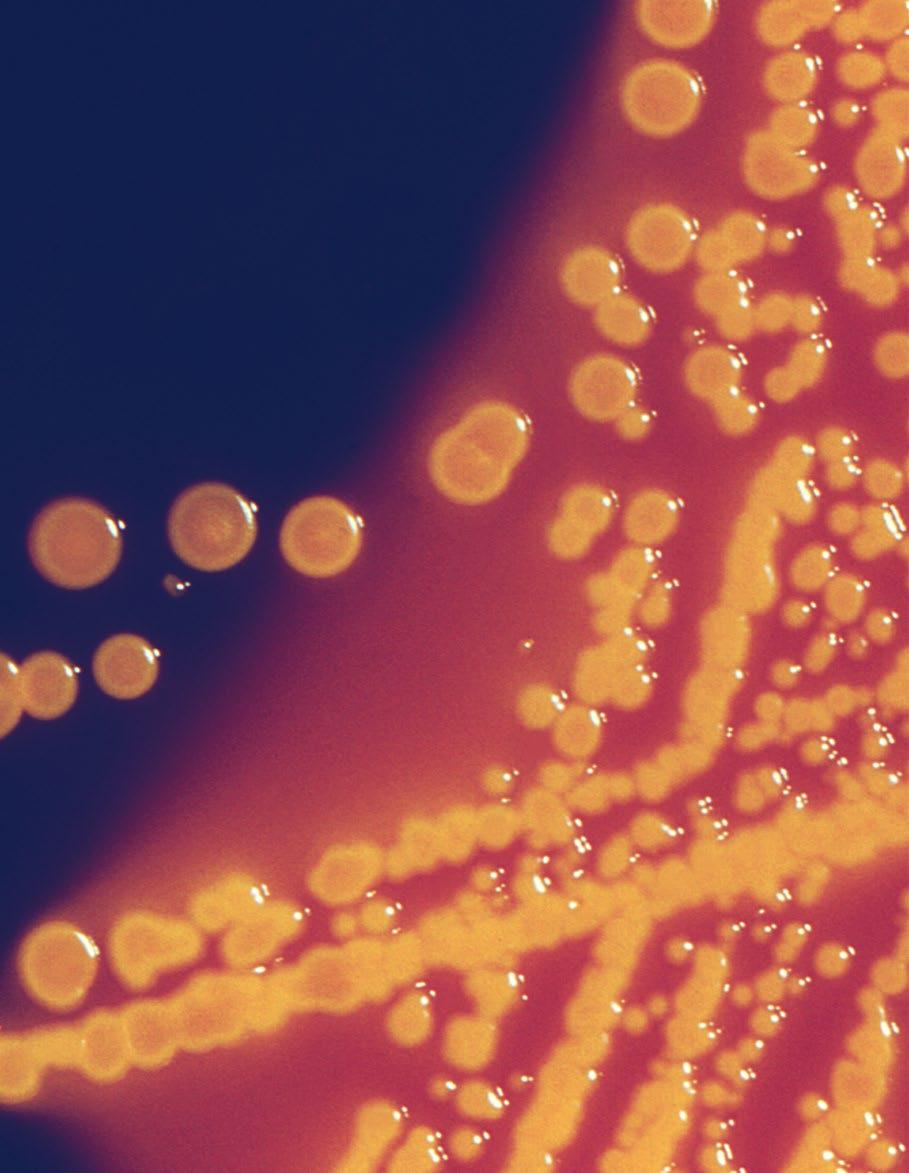

FORSKNING, DER FREMMER SUNDHEDEN
Sådan kan bioteknologi hjælpe i kampen mod alvorlige sygdomme

FORSKERE SKANNER STOR GULDSKAT FRA JERNALDEREN NY METODE: Fra sukker til plastik DYNAMO SPØRGER: Hvorfor er der modstand mod vindmøller? ASTEROIDE SKAL UDFORSKES MED DTU’S MAGNETOMETER NR. 74 09 2023 DANMARKS TEKNISKE UNIVERSITET DTU – TEKNOLOGI FOR MENNESKER TEMA
DTU-instrument til NASA
Metal-asteroide skal udforskes med et magnetometer fra DTU.

Hvad gør vi med vindmøllemodstand?
Plastik af sukker
Ny metode udnytter effektivt biomassens sukker til fremstilling af plastik.

Hvad stiller vi op med, når ingen ønsker de store anlæg til grøn omstilling i baghaven? Det har lektor Julia Kirch Kirkegaard nogle bud på. UDGIVER

08-23
TEMA
Bioteknologi bag ny medicin
Med bioteknologiske værktøjer udvikler forskere nye løsninger til behandling af alvorlige sygdomme som kræft og parkinson.

04
26
30
Danmarks
Anker
2800 Kgs. Lyngby, tlf. 45 25 25
Peter
REDAKTION Lotte
Miriam
Fotocredits:
02 INDHOLD
Tekniske Universitet,
Engelunds Vej 101A
25, dtu.dk ANSV. CHEFREDAKTØR
Trads
Krull, lkru@dtu.dk
Meister, mirme@dtu.dk ABONNEMENT dynamo@dtu.dk Magasinet udkommer fire gange om året DESIGN & PRODUKTION Creative ZOO ISSN 1604-7877 FORSIDEFOTO
Getty Images
Algoritmer skal forhindre frugtesløse eksperimenter
Kvanteinspirerede algoritmer skal forkorte tiden fra idé til produkt i udviklingen af nye kemikalier.
Guldskatten skannes
3D-skanning af et stort guldfund fra Østjylland skal afsløre ny viden om jernalderen.

Ny indretning af lakridsfabrik
Studerende har udarbejdet en plan for Bagsværd Lakridsfabrik.
Bioteknologi til gavn for mennesker
Det ligger dybt i vores ingeniørfaglighed at have fokus på anvendelse: De nye løsninger, der udvikles, skal ud af laboratorierne og gøre nytte i det omgivende samfund. Det gælder også de bioteknologiske løsninger, som bekæmper sygdomme og fremmer sundhed. Derfor har flere af vores forskere gennem mange år samarbejdet tæt med hospitalssektorens læger og sygeplejersker, som har såvel den medicinske faglighed som patientkontakten.
Dette samarbejde skruer vi nu op for: Denne sommer underskrev DTU og Rigshospitalet en hensigtserklæring om at etablere et strategisk partnerskab for at styrke udvikling og udnyttelse af teknologiske sundhedsløsninger.

Partnerskabet står på skuldrene af det hårde arbejde, som frontløbere i begge vores organisationer har udført i mere end et årti. Det er en indsats, som har omfattet mere end udvikling og implementering af ny medicin og teknologiske løsninger i sundhedssek-
toren. Det har også ført til etablering af samarbejdsuddannelsen Medicin og Teknologi samt delestillinger, der gør det muligt at f.eks. Rigshospitalets læger også arbejder på DTU, mens vores ingeniører kan lægge noget af arbejdstiden på Rigshospitalet.
Vores partnerskab skal åbne flere døre og nedbryde tidsrøvende administrative barrierer, så det bliver nemmere for vores innovative medarbejdere at finde frem til hinanden og starte nye projekter, hvor de opfinder og tester løsninger til gavn for fremtidens patienter.
Bioteknologi er en integreret del af ingeniørfagligheden. Det er helt naturligt, i betragtning af at bioteknologi er et felt, der handler om teknologisk anvendelse af biologiske byggesten som kulhydrater og proteiner og systemer som mikrobiomer samt levende organismer som f.eks. gærceller og mikroalger.
Naturligvis er det noget, vi beskæftiger os med på et teknisk universitet. Her anvender
Idéer til fremtidens Roskilde Festival
15 studenterprojekter til en sjovere, grønnere og mere sikker festival blev testet på årets Roskilde Festival.

vores forskere de bioteknologiske værktøjer til bl.a. at udvikle nye metoder til målrettet behandling af alvorlige sygdomme.
I nærværende magasin kan du læse om nogle af disse projekter.
Anders Bjarklev Rektor

32 40 36 42
LEDER
03 DYNAMO NR. 74 09 2023 DTU
Fintfølende instrumenter skal udforske metal-asteroide
NASA’s rummission til asteroiden Psyche, som befinder sig i asteroidebæltet mellem Mars og Jupiter, skal hjælpe os med bedre at forstå vores egen Jord. DTU bidrager med instrumenter, der kan måle og kortlægge asteroidens magnetfelt.

Dybt inde i midten af Jorden er en kerne af metal – så varm og så langt inde, at det ikke kan lade sig gøre at komme ind og studere den. Men man kan måske få noget at vide om den og de andre jordlignende planeters kerner ved at studere asteroiden Psyche. Ud fra de observationer, man har gjort gennem teleskoper, antager
man nemlig, at den består af 60 pct. metal – sandsynligvis en legering af jern og nikkel. Psyche, der nærmest ligner en kartoffel og måler ca. 150 x 250 km, kan faktisk være det inderste af en planet, som efter en ødelæggende kollision med et andet objekt har mistet det ydre lag.
Til oktober sender NASA en mission til Psyche. Det bliver den fjortende i NASA’s Discovery Program. Forberedelserne startede i 2017 med planlagt afsendelse i 2022, men bl.a. på grund af coronaepidemien kunne NASA ikke nå at gennemføre alle tests inden da. Der er forholdsvis få tidspunkter på året, hvor rejsen passer ind i planeternes stilling. Næste vindue er oktober 2023. Med ombord på rumfartøjet vil være tre videnskabelige instrumenter: et avanceret kamera til kortlægning og overfladeundersøgelser, et gammastrålings- og neutronspektrometer, der kan måle, hvilke stoffer asteroiden består af, og et magnetometer. Det sidste er bygget på DTU.
”Vi blev inviteret med, fordi vores magnetometer ved flere forskellige
2 Marianne Vang Ryde
3 NASA, DTU
04 RUMMISSION
rummissioner har bevist sin enestående evne til at måle et meget bredt og ekstremt nøjagtigt magnetfelt. I 2020 begyndte vi at samarbejde med Massachusetts Institute of Technology (MIT), som leder Psyche Magnetometry Investigation. Og i 2021 var vi de første, som leverede et færdigt videnskabeligt instrument til rumskibet, som bliver bygget hos NASA Jet Propulsion Laboratory i Pasadena,” fortæller professor på DTU Space José M.G. Merayo, der også er co-investigator (forskningsleder) og medlem af Psyche-missionens videnskabelige team.


Lille instrument – stor spændvidde Magnetometret er forbavsende lille i forhold til sin ydeevne og kapacitet. Sensoren er på størrelse med en tennisbold placeret i en cylinder og med en overflade, der kunne minde om en ananas. Rillerne på overfladen holder spoler, som genererer et magnetfelt svarende til det, som man gerne vil måle. Selve rumskibet måler 3,1 x 2,4 meter, når solpanelerne ikke er foldet
ud, og er altså ikke meget større end en smart bil. Det vejer knap to ton uden brændstof og knap tre med, så magnetometrets ca. 2 kg er ikke meget i sammenligning. Men det er effektivt og pålideligt, udviklet og bygget manuelt på DTU med fokus på hver eneste lille detalje.
Man ved intet om Psyches magnetfelt – hverken om det er stort eller småt, eller om det er ét stort felt eller samlet i mindre felter forskellige steder. Magnetometret skal være klar til det hele.
DTU’s magnetometer er unikt ved uhyre præcist at kunne måle størrelsen og retningen på magnetfelter. Magnetfelter opgøres sædvanligvis i måleenheden tesla. Hvis magnetfeltet er meget svagt, så angiver man målene
Asteroider
Asteroider er himmellegemer, der er for små til at blive kaldt planeter. De fleste asteroider kredser om Solen i asteroidebæltet mellem Mars og Jupiter. Selvom der er millioner af asteroider i dette bælte, så ville deres rumfang være mindre end Månens, hvis man samlede dem i én klump.
Kilde: vildmedrummet.dk
Rumsonden skal gennemføre en rejse, der varer i seks år, før den når frem til asteroiden Psyche, hvor den i lidt over to år er i kredsløb for at lave de ønskede målinger.
med nanotesla (nano = 10-9). Jordens magnetfelt målt i Danmark er ca. 54.000 nanotesla.
Magnetometret fra DTU har en spændvidde, der er så stor, at det kan registrere magnetfelter, der er så svage, at de blot måler 0,025 nanotesla, og så stærke, at de måler helt op til 80.000 nanotesla. Det vil sige, at det svageste magnetfelt, instrumentet kan måle, er 6 mio. gange lavere end det stærkeste felt, det kan måle. Eller med andre ord: Instrumentet kan opfange magnetfelter
DTU 05 DYNAMO NR. 74 09 2023
lige fra solvindens svage felter til større planeters stærkere magnetfelter.
155 års funktion i rummet
Der er to magnetometre med på turen for at sikre data, hvis der skulle ske noget med et af dem. Men der er også en anden grund:
”Rumskibet kan i sig selv generere et magnetfelt, og det ønsker vi ikke at have med i vores data. Derfor sidder instrumenterne et stykke fra rumskibet på en bom, og med to sensorer kan vi detektere signaler fra rumfartøjet og trække dem fra. Hvis de to sensorer måler det samme, antager vi, at det er det naturlige magnetfelt. Hvis de måler forskelligt, går vi ud fra, at det kommer fra rumskibet,” forklarer José Merayo. José Merayos forskningsgruppe på DTU Space har bygget magnetometre til flere missioner, der har målt på Jordens magnetfelt. Først til satellitten Ørsted og siden til den tyske mission CHAMP og European Space Agencys SWARM-mission.
”Sammenlagt har vores magnetometer været i funktion i rummet i mere end 155 år, og vores målinger danner bl.a. grundlag for de geomagnetfeltkort, der bruges til navigation, og i tilfælde af at GPS går ned,” siger José Merayo.
Magnetometrene på Psyche-missionen får strøm fra solpanelerne, som sidder på rumskibet, og begynder at måle straks efter afsendelsen. Instru-
I mindst så mange år har magnetometre fra DTU sammenlagt været i brug i rummet.
Forskere ved DTU Space har udviklet og leveret to magnetometre til NASA. Instrumenterne skal stå for målinger af Psyches magnetfelt.



mentet er selvfølgelig testet i alle ender og kanter inden afsendelsen, men det skal tjekkes, om alt virker som ventet, eller noget skal rettes til, når det faktisk er i rummet.
Seks års rejse
Psyche ligger i asteroidebæltet mellem Mars og Jupiter, og på den 500 mio. km lange rejse bliver der måske også mulighed for at få data om Mars’ omgivelser, når rumskibet flyver tæt forbi planeten, ligesom der sikkert vil kunne hentes ny viden om solstorme og deres indvirkning på solsystemet. Instrumentet bliver i hvert fald holdt tændt på hele turen, selvom man godt kunne slukke og tænde.
Efter seks års rejse når missionen forhåbentlig frem til den metalliske asteroide, og så er planen, at fartøjet skal cirkulere i fire forskellige baner, henholdsvis ca. 700, 500, 300 og 100 km fra den, i mere end to år tilsammen. Det vil give en mængde nye data og dermed forhåbentlig bidrage til forståelsen af, hvordan vores solsystem og planeternes magnetfelt blev skabt.
”Hvorfor har nogle planeter, som f.eks. Venus, ikke noget magnetfelt, mens andre, f.eks. Jupiter, har magnetfelter, der er meget kraftigere end Jordens? På Psyche har vi den nøgne kerne, som vi kan måle direkte på. Det regner vi med, vil fortælle os meget. Ved at lære mere om Psyches magnetfelt kan vi også blive klogere på, hvordan Jordens magnetfelt fungerer. Solsystemet er kæmpestort, og alt, hvad vi kan få af data, hjælper os med at forstå det bedre – f.eks. hvordan vejret i rummet er med til at beskytte vores Jord,” siger José Merayo.
Der er ingen planer om at hente rumskibet hjem, når missionen er slut.
”Måske lander det på Psyche, hvem ved? Eller det bliver til en lille kunstig måne til asteroiden,” siger José Merayo. 1
06 XXXXXXXXXX XXXXXXXXXX DTU DYNAMO NR. 74 09 2023 DYNAMO NR. 74 09 2023 DTU 06 RUMMISSION
5 José M.G. Merayo, professor, DTU Space, jmgm@space.dtu.dk
155
4 Find mere information om Psyche- missionen på psyche.asu.edu.
Rumsonden blev bygget på NASA’s Jet Propulsion Laboratory i Californien, USA.
GRØNNE INGENIØRSPIRER
Et filter, der kan rense store mængder regnvand kun ved brug af klor, el og salt, en bionedbrydelig tallerken lavet næsten udelukkende af tang (se billedet) og et næringsrigt proteinpulver baseret på de dele af rejer, som normalt bliver smidt ud. Disse
bæredygtige idéer dystede med mere end 60 andre ved DTU’s årlige studenterkonference Grøn Dyst i juni. Uddannelsesinitiativet skal ruste fremtidens ingeniører til at integrere aspekter af social, økonomisk og miljømæssig bæredygtighed i deres arbejde.

FRISK PUST TIL EFTERUDDANNELSE
DTU’s gratis, online efteruddannelse i vindenergi har haft vind i sejlene siden lanceringen for otte år siden. Mere end 150.000 studerende fra hele verden har i den tid fulgt uddannelsen, som nu er blevet relanceret, så DTU Winds seniorforskere og professorer i 16 nye forelæsninger kan formidle det nyeste fra deres banebrydende forskning til endnu flere.
Uddannelsen tager otte uger at gennemføre og har et fagligt niveau på linje med DTU’s bacheloruddannel-
ser. Forelæsningerne bliver suppleret af øvelser og fagtekster, der kan løses og læses på alle tider af døgnet. Institutdirektør på DTU Wind Morten Willaing Jeppesen ser den gratis, engelsksprogede, digitale efteruddannelse som en demokratisering af forskernes viden, der så kan væres med til at øge brugen af vindenergi globalt.
4 Læs mere om uddannelsen på dtu.dk/windcoursera

DTU DYNAMO NR. 74 09 2023 07 NYHEDER UDDANNELSE
”Det er ikke med vores gode vilje, at vi i år bliver nødt til at optage færre studerende. Særligt når vi kan se en markant stigning i antallet af ansøgere. Vi burde optage flere end sidste år – ikke færre.”
SÅ MANGE KUNNE DTU TILBYDE EN STUDIEPLADS EFTER DEADLINE FOR ANSØGNING PÅ KVOTE 2. TRODS EN 9 PROCENT STIGNING I ANSØGNINGER FRA SIDSTE ÅR OPTAGES FÆRRE, FORDI EN POLITISK AFTALE TVINGER DTU TIL AT REDUCERE ANTALLET AF STUDIEPLADSER FREM MOD 2030.
Bachelordekan Lars D. Christoffersen.
2.283
3 Mikal Schlosser og Troels Friis Pedersen
Forskning, der fremmer sundheden

BIOTEKNOLOGI
08 TEMA: BIOTEKNOLOGI
Bioteknologi bag ny medicin




Ved at undersøge de mindste biologiske byggesten som proteiner og kulhydrater og ved at forstå de mindste organismer som bakterier og celler – lige fra stamceller og T-celler til kræftceller – kan vi ved hjælp af bioteknologiske værktøjer udnytte vores viden til at fremme sundheden hos mennesker. Vi kan udvikle nye metoder til tidligere diagnosticering af alvorlige sygdomme, opfinde nye lægemidler og skabe revolutionerende behandlingsmetoder.
Danmark har en stærk forskningstradition inden for bioteknologi og tiltrækker dygtige forskere og investeringer til området. Det er tydeligt, at dansk bioteknologi har fart på. I tiårsperioden 2008-2018 har branchens årlige vækst været på 6 pct., hvilket er tre gange højere end den gennemsnitlige vækst i det samlede private erhvervsliv.
Branchen er en del af life science-sektoren, der i Danmark beskæftiger 50.000 mennesker, og tal fra Danmarks Statistik viser, at der fra 2015 til 2020 har været en stigning på 30 pct. i antallet af kandidater med en lang videnskabelig uddannelse inden for teknisk videnskab, som bliver ansat i sektoren. DTU samarbejder tæt med virksomheder i life sciencesektoren om både uddannelse af de ingeniører, som sektoren har brug for, og om den forskning, som skaber nye løsninger inden for sundhed og medicin.

På de følgende sider kan du læse eksempler på forskningsprojekter, der vil forandre diagnosticering og behandling af alvorlige sygdomme som bl.a. kræft og parkinson. Du kan også læse et interview om de etiske udfordringer,
 som teknologien giver os.
som teknologien giver os.
TEMA
14 SKÅNSOM BEHANDLING MOD E. COLI MÅLRETTET BLODKRÆFTPATIENTER
16 T-CELLETERAPI: NY KRÆFTBEHANDLING TESTES I PATIENTER
18 HJERNEMODEL ÅBNER FOR AT TESTE MEDICIN MOD PARKINSONS SYGDOM
21 BRUG AF BIOTEKNOLOGI KRÆVER GRUNDIG OMTANKE
09 DYNAMO NR. 74 09 2023 DTU
10 KEMIKERE FORBEDRER LÆGEMIDLER TIL KRÆFTBEHANDLING
Kemikere forbedrer lægemidler til kræftbehandling
Medicin, der infiltrerer kræftcellerne og dræber dem indefra, bliver ekstra effektiv efter at have været i hænderne på en gruppe kemiforskere.
De senere år har verden set en ny gruppe lægemidler til behandling af kræft, som bedst kan beskrives som medicinens svar på trojanske heste. Som små og harmløse ’pakker’ cirkulerer lægemidlet i patientens blodbane, indtil det møder en kræftcelle. Her inviteres det indenfor. Inde i kræftcellen går den uskyldige gæst i gang med sit egentlige – og for kræftcellen ondsindede – ærinde: Den udløser sin giftige last, der dræber kræftcellen.
Sagen lyder enkel, men det er den ikke. For nogle gange bliver den ’trojanske kræftmedicin’ inviteret ind i raske celler, der dermed dør, og det er naturligvis ikke ønskeligt. Andre gange frigives medicinen for tidligt, altså imens den stadig cirkulerer i blodbanen, og dermed mindskes virk-
ningen af behandlingen, da mindre mængder af medicin når frem til deres egentlige bestemmelsessteder, nemlig kræftcellerne. Sidst, men ikke mindst, så er der nogle kemiske benspænd, der gør, at det er ret få lægemidler, man kan få koblet på de trojanske medicinheste. Denne nye gruppe af lægemidler kaldes for antistoflægemiddel-konjugater, forkortet som ADC (fra det engelske udtryk antibody-drug conjugates). Et ADC består af et antistof, der skal genkende kræftcellen, samt et stof, der skal dræbe kræftcellen. De

10
2 Lotte Krull
3 Bax Lindhardt, Claus Lunau
TEMA: BIOTEKNOLOGI
to stoffer bliver holdt sammen af et kemisk molekyle, kaldet en linker. I dag findes der kun ca. et dusin ADC’er i verden.
For at et ADC virker efter hensigten, er det afgørende, at linkeren er stabil i blodbanen og effektivt slipper det virksomme stof, der skal dræbe kræftcellen. Kemiker Katrine Qvortrup, lektor ved DTU, har gennem de sidste par år forsket i, hvordan linkermolekylet kan forbedres.
”Der var i forskningskredse bred enighed om, at et nyt design af linkeren kunne forbedre ADC’erne på flere punkter: Vi ville kunne øge ADC’ets selektivitet, dvs. sikre os, at det bliver bedre til kun at ramme kræftcellerne, og vi kunne undgå ineffektivitet, bl.a. ved at sikre os, at medicinen ikke bliver frigivet for tidligt, og endelig var der også potentiale for, at en forbedring kunne føre til, at vi kan koble flere slags lægemidler på linkeren, end man har kunnet hidtil,” siger Katrine Qvortrup.
Linkeren skal kløves Antistoffet er en vigtig del af ADC’et, da det bevirker, at hele den lille kemiske pakke genkender en kræftcelle og bliver lukket ind i den. Dette sker via et antigen, der sidder på ydersiden af kræftcellen. Antigenet er unikt ved at være til stede på celler, der vokser hurtigt, hvilket er tilfældet for mange kræftceller.
Lektor Katrine Qvortrup tv. og postdoc Katja Egeskov Grier er begge ansat på DTU Kemi, hvor de udvikler et nyt lægemiddel, der kan finde frem til kræftceller inde i kroppen og dræbe cellerne indefra.
Om ADC
• ADC er en forkortelse af det engelske udtryk antibody-drug conjugates, på dansk antistoflægemiddel-konjugater.

• ADC er en forholdsvis ny klasse af terapeutiske midler til behandling af kræft.
• Der findes kun 11 slags ADC’er på markedet indtil videre.
• ADC’er består af et antistof, som kan identificere kræftceller, og en last af stof, som kan ødelægge cellen.
• Lasten kan bestå af enten kemo, toksiner eller stråling.
KILDER: UGESKRIFT FOR LÆGER OG LEKTOR
KATRINE QVORTRUP
11 DYNAMO NR. 74 09 2023 DTU
”Vi får målrettet lægemidlet endnu mere præcist mod kræftcellerne, og det giver behandlingen større effektivitet og færre bivirkninger, fordi de raske celler går fri.”
LEKTOR KATRINE QVOTRUP, DTU
Strategisk partnerskab
DTU og Region Hovedstaden ønsker at styrke samarbejdet mellem universitetet og regionens hospitaler om uddannelse, forskning, innovation og behandling.
I juni blev en hensigtserklæring underskrevet af DTU’s rektor og Rigshospitalets direktør på vegne af Region Hovedstaden. Hensigtserklæringen går ud på at øge samarbejdet og etablere et strategisk partnerskab inden for rammerne af et universitetshospital for at styrke udvikling og udnyttelse af teknologiske sundhedsløsninger til fremtidens patienter.
Antigenet fungerer som receptor, så når antistoffet i et ADC møder kræftcellens antigen, opstår der genkendelse, og vores trojanske ven bliver ’inviteret’ indenfor. Uheldigvis findes der almindelige raske celler med lignende antigener, fordi de også vokser hurtigt, såsom hår-, negle- og knoglemarvsceller, og disse celler vil gå til, hvis ADC’et bliver lukket ind.

Så Katrine Qvortrup og hendes kolleger begyndte derfor at kigge på, hvorledes man kunne sikre sig, at den giftige last kun bliver udløst i kræftcellerne og ikke i de andre hurtigvoksende celler. Forskerne stillede derfor skarpt på de forhold i kræftcellens indre, som adskiller sig fra den raske celle. Måske kunne de finde en forskel, som kunne udnyttes, så ADC’et kun bliver aktiveret i kræftcellen.
åbner den sig, og lægemidlet bliver sluppet fri,” forklarer Katrine Qvortrup.
Særligt enzym i visse kræftceller
Det fik forskerne til at interessere sig for et enzym kaldet sulfatase, som findes i højere koncentrationer inde i visse kræftceller. Typisk ses de højere koncentrationer af sulfatase ved kræftformer, som er hormonelt drevet, dvs. prostatakræft og visse former for brystkræft. Med denne viden arbejdede forskergruppen på at designe linkeren, så den kun kløves, når den møder sulfatase.
Katrine Qvortrup bruger sin faglige baggrund som kemiker til at designe nye molekyler i laboratoriet, som kan forbedre lægemidler.
”For at en linker frigiver lægemidlet inde i cellen, skal den først kløves. Noget skal aktivere denne kløvning. Linkere kan kløves på flere måder, og en af dem er ved hjælp af enzymer. Så når linkeren møder et bestemt enzym,
Under udviklingen af linkeren arbejdede forskerne tæt sammen med Finsenlaboratoriet, som er Rigshospitalets kræftforskningsafdeling. Finsenlaboratoriet testede løbende de versioner af linkeren, som blev udviklet, indtil DTU-forskerne lykkedes med at opnå de ønskede egenskaber.
”Med vores nye linker har vi tilføjet en form for ekstra lag af sikkerhed, der gør, at ADC’et først optages af en hurtigvoksende celle og dernæst kun kan udløses, hvis der er sulfatase til stede. Det betyder, at skulle ADC’et komme ind i en hurtigvoksende, rask celle, sker der ingenting, for der er ikke nok sulfatase til stede. På den måde får vi målrettet lægemidlet endnu mere præcist mod kræftcellerne, og det giver behandlingen større effektivitet og færre bivirkninger, fordi de raske celler går fri,” siger Katrine Qvortrup.
Ændrer størrelsen på antistofferne
Forskerne er derudover lykkedes med flere forbedringer af linkeren ved at ændre på linkerens kemiske funktionaliteter, heriblandt at øge dens vandopløselighed. Det er med til at gøre ADC-konstruktionen mere stabil, hvilket igen øger effektiviteten af lægemidlet. Desuden fik de også designet linkeren således, at der kan kobles flere typer lægemidler på, hvilket gør det muligt at benytte ADC’er til at angribe langt flere sygdomme med.
Sidst, men ikke mindst begyndte de også at ændre på antistoffets størrelse, så man kan bruge et mindre molekyle til at levere det giftige lægemiddel.
”Et antistof er et ret stort molekyle, og det forhindrer ADC’et i at trænge ind i metastaser, hvor kræftcellerne er supertæt pakket. Vi har derfor udviklet
12
TEMA: BIOTEKNOLOGI
stoffer: et antistof og det stof, som skal dræbe kræftcellen.
På kræftcellernes ydre sidder antigener, som optræder på celler, der vokser hurtigt. Antistoffet i ADC’et kan genkende antigenet, og ADC’et optages af kræftcellen.
’nanobodies’, som er væsentlig mindre molekyler end de antistoffer, der hidtil er brugt i ADC’er. På den måde kan vi snige ADC’et ind i metastaser,” siger Katrine Qvortrup.
Inspirationen til den løsning fandt forskerne i den videnskabelige litteratur, der beskriver en speciel receptor på kræftceller, som ikke er blevet udnyttet tidligere. Forskerne fik udviklet deres ’nanobodies’ til at genkende denne receptor, så et ADC nu både kan komme ind i metastaserne og helt ind i kræftcellerne her.

DTU-forskerne har fået udført yderligere analyser af den nye linkerteknologi hos den private virksomhed
Abzena, som er specialiseret i dette felt. Teknologien er patenteret.
”Vi er nu i gang med nogle finjusteringer af vores linker, ligesom der bliver lavet flere tests af den, så vi får indsamlet mere viden om dens funktionaliteter. Al forskningen har vi publiceret i foråret 2023, og snart er vi klar til at sælge teknologien, så den kan komme ud og blive anvendt i bekæmpelsen af kræft,” siger Katrine Qvortrup. 1
Inde i visse kræftceller er der en forhøjet koncentration af enzymet sulfatase. Det reagerer ADC’ets linker på. Den kløves, og dermed frigives det stof, som fører til kræftcellens død
2.
3.
DTU DYNAMO NR. 74 09 2023 13
5 Katrine Qvortrup, lektor, DTU, kaqvo@kemi.dtu.dk
Skånsom behandling mod E. coli målrettet blodkræftpatienter
Forskere fra DTU står bag et muligt nyt lægemiddel, som kan være et skånsomt alternativ til antibiotika, når patienter med blodkræft skal behandles for infektioner med E. coli-bakterier. Nu skal midlet afprøves på mennesker.
Mange danskere har prøvet at blive ramt af en E. coli-infektion, som for de fleste primært er en ubelejlig og ubehagelig oplevelse, hvor man gerne skal være tæt på et toilet i et par dage. For f.eks. blodkræftpatienter risikerer bakterierne dog at trænge ind i blodbanen – og sker det, ender 15-20 pct. af patienterne faktisk med at dø af infektionen.
E. coli-infektioner behandles normalt med antibiotika, som dog har en skadelig indvirkning på sammensætningen af bakterier i patientens tarm, også kaldet mikrobiomet. Mikrobiomet spiller en vigtig rolle for vores fysiske og psykiske velbefindende. Desuden gør de stigende udfordringer med

resistens også antibiotikabehandlinger mindre effektive mod infektioner.
Udnytter små dræbere
Nu har professor Morten Otto Alexander Sommer sammen med sine kolleger på DTU og et team af forskere fra USA og Slovenien udviklet den første beskrevne CRISPR-baserede lægemiddelkandidat, der er direkte målrettet E. coli-bakterier, og som efterlader mikrobiomet intakt.
Med CRISPR-teknologien kan forskerne tilpasse DNA-sekvenser i celler ved at klippe i DNA’et og derefter enten rette DNA’et til eller tilføje et nyt stykke DNA. Forskerteamet har i udviklingen af lægemiddelkandidaten brugt CRISPR til at designe fire ’fager’,
14
2 Tore Vind Jensen
TEMA: BIOTEKNOLOGI
3 Centers for Disease Control
så de går målrettet efter de uønskede E. coli-bakterier og dræber dem. Fager er små virus, der kan dræbe specifikke bakterier. De findes naturligt overalt på jorden og hjælper med at regulere bakteriepopulationer og næringsstofkredsløb. De inficerer og dræber bakterier, og når bakterierne dør, frigiver de næringsstoffer i miljøet.
Brugen af fager til at behandle bakterieinfektioner kaldes fagterapi. Denne terapiform har visse fordele i forhold til antibiotika, f.eks. at fagerne er målrettet specifikke bakterier, som de kan dræbe uden at påvirke andre bakterier i mikrobiomet. Brugen af fager kan også være med til at mindske antibiotikaresistens.
”Vi mener, at et lægemiddel med netop disse egenskaber kan være meget nyttigt for bl.a. kræftpatienter, som ofte får alvorlige infektioner, der er vanskelige at behandle med de nuværende antibiotika,” forklarer Morten Otto Alexander Sommer.
Forskernes arbejde er nu så langt, at lægemiddelkandidaten er klar til at blive afprøvet på mennesker.
Blodkræftpatienter forrest i køen
Forskernes arbejde er særligt spændende for blodkræftpatienter. Det skyldes, at de oplever forskellige bivirkninger af kemoterapibehand-
lingen. F.eks. får kemoterapien deres knoglemarv til at producere færre blodlegemer og kan give betændelse i tarmene. Sidstnævnte øger tarmens gennemtrængelighed, så bakterier fra tarmen kan trænge ind i blodbanen. Denne kombination af bivirkninger gør patienterne sårbare over for infektioner forårsaget af bakterier som E. coli.
I dag modtager patienter i risikogruppen (dvs. med lave niveauer af hvide blodlegemer) antibiotikabehandlinger forud for deres kemoterapi, men i nogle tilfælde udviser E. coli-bakterier meget høj resistens over for almindeligt anvendte antibiotika. Antibiotika forårsager desuden i sig selv flere bivirkninger, der i nogle tilfælde nedsætter effekten af kræftbehandlingerne.
”Vi har brug for en bredere vifte af behandlingsmuligheder for disse patienter, og helst nogle, der er specifikt målrettet bakterierne for at undgå bivirkninger, og som ikke forværrer problemet med antibiotikaresistens,” siger Morten Otto Alexander Sommer.
På grund af stigningen i antibiotikaresistens er interessen for alternativer vokset, og forskere er i de senere år begyndt at udvikle fager til behandling af infektioner. Før antibiotika blev alment tilgængelig, var brugen af fager meget udbredt og blev studeret i lande i det tidligere Sovjetunionen. Alligevel er der kun udført få kliniske forsøg, som ifølge forskerne bag den nye lægemiddelkandidat ikke har været overbevisende. Det er udviklingen af nye teknologier som CRISPR, der har gjort det muligt målrettet at arbejde på egentlige terapier baseret på fager.
”Som vores resultater viser, er der potentiale for at tilpasse naturligt forekommende fager ved hjælp af genteknologi. Det er mit håb, at denne tilgang også kan tjene som inspiration til nye antimikrobielle stoffer, der er målrettet resistente patogener,” siger Morten Otto Alexander Sommer. 1

DYNAMO NR. 74 09 2023 DTU 15
5 Morten Otto Alexander Sommer, professor, msom@bio.dtu.dk
Hvor infektioner med E. coli-bakterier i de fleste tilfælde forårsager forbipasserende gener, kan de hos personer med blodkræft være decideret livsfarlige.
”Vi har brug for en bredere vifte af behandlingsmuligheder for disse patienter, og helst nogle, der er specifikt målrettet bakterierne for at undgå bivirkninger, og som ikke forværrer problemet med antibiotikaresistens.”
PROFESSOR MORTEN OTTO ALEXANDER SOMMER, DTU
Ny kræftbehandling testes i patienter
Forskere på DTU kan forbedre immunforsvarets T-celler, så de angriber kræftceller hos visse patienter med modermærkekræft. I samarbejde med Herlev Hospital afprøves løsningen nu på patienterne.

Procedurerne er blevet raffineret, og de stoffer, som bruges til at påvirke T-cellerne, er kvalitetssikret. Og for godt et år siden var alt klar til at starte et egentligt klinisk forsøg på Herlev Hospital.
Første mål er modermærkekræft
Professor Sine Reker Hadrup fra DTU har gennem mange år forsket i, hvordan man kan udnytte T-celler til kræftbehandling. T-celler er en særlig type af hvide blodlegemer, som spiller en vigtig rolle i vores immunforsvar. Senest har hendes forskningsgruppe udviklet en metode til at forbedre T-cellers evne til at genkende kræftceller og opformere dem – dvs. øge antallet af dem – til en hel angrebshær.
I første omgang er dette foregået i laboratoriet med mindre blodprøver fra patienter, men efterhånden er processen så veludviklet, at den er blevet klar til at køre i større skala.
”Vi tager en pose blod fra patienterne, finder og opformerer de T-celler, der er i stand til at genkende antigener på overfladen af kræftcellerne, og giver derefter cellerne tilbage til patienterne,” forklarer Sine Reker Hadrup.
I første runde omfattede forsøget patienter med fremskreden modermærkekræft, som havde været igennem flere standardbehandlinger uden væsentlig bedring af sygdommen. Deltagerne skulle yderligere have vævstype HLA-A2, som ca. 40 pct. af alle mennesker i Europa har. Og et tredje udvælgelseskriterium var, at patientens blod allerede skulle indeholde en lille mængde af den type T-celler, som evner at tackle kræftcellerne.
Foreløbig har fem patienter modtaget denne behandling.
”Det er jo et meget lille forsøg, som primært skulle vise noget om behandlingens sikkerhed. Vi er først nu ved at analysere alle data, men kan heldigvis konstatere, at der ikke har været nogen bivirkninger. Vi skal også sikre os, at de celler, vi giver tilbage til patienterne, faktisk bliver i kroppen. Men vigtigst af alt håber vi at se en forbedring i for-
16
2 Marianne Vang Ryde
3 Wikimedia Commons, Claus Falkenberg Thomsen
TEMA: BIOTEKNOLOGI
T-celler er en særlig type af hvide blodlegemer, der findes i vores immunforsvar.
hold til tumorens størrelse hos nogle af patienterne,” siger Sine Reker Hadrup.
Skal udbredes til flere kræftformer
Sideløbende med dette kliniske forsøg arbejder professoren og hendes team stadig på at videreudvikle og raffinere teknologien.
”Vi ser på andre mulige kræftformer, hvor det vil være relevant at bruge teknologien. Specielt har vi arbejdet med den sjældnere form for hudkræft, merkelcelle karcinom, som er virusdrevet. Vi har tidligere karakteriseret, hvilke sekvenser fra denne virus immunforsvarets T-celler er i stand til at genkende. Derfor kan vi nu lave et bibliotek af sekvenser, som vi ved, er relevante, og så kan vi mikse og matche dem afhængigt af patientens vævstype. Det vil gøre os i stand til at lave nogle produkter, som kan bruges på et større udsnit af patienter – i hvert fald 90 pct. af alle vævstyper. Det virker i laboratoriet, og vi håber snart at kunne gå videre med det i et klinisk forsøg,” siger Sine Reker Hadrup.
En af de store udfordringer med T-celle-teknologien er, at det er en tung proces, som kræver meget logistik, adgang til avancerede laboratorier såsom renrum samt processering og behandling på hver enkelt patients blodceller. Så det er urealistisk, at den skulle kunne blive standard for bredere patientgrupper.
”Men arbejdet med den lærer os meget om immunforsvaret, og den viden vil vi gerne bruge til at lave nye teknologier, som er lige til at tage ned fra hylden. Vi bevæger os over imod ikke at arbejde med patienternes egne celler, men generere celler fra stamcellelinjer eller donorer med en matchende vævstype, så de kan ligge klar i fryseren, når der er brug for dem. Så vil flere patienter kunne få glæde af det, og man vil eliminere ventetiden fra beslutningen om at behandle med T-celleterapi til den faktiske behandling. Ellers vil produktionsfasen mange gange strække sig over flere uger,” siger Sine Reker Hadrup.
Nanopartikler på vej
Et nyere spor i forskningen åbner endnu større perspektiver. Sammen med en anden forskningsgruppe på DTU Sundhedsteknologi, som ledes
af lektor Yi Sun, og professor Hinrich Abken fra Regensburg Universitetsklinik er Sine Reker Hadrups gruppe nemlig i fuld gang med at udvikle nogle nanopartikler, som, når de injiceres i patienten, selv kan finde hen til de T-celler, der skal trænes til at nedkæmpe kræftcellerne.
Forskerne udstyrer nanopartiklerne med antistoffer, som gør, at de kan optages af T-celler, og de skal medbringe genetisk information, som sætter T-cellerne i stand til bedre at genkende kræftcellerne.

Alle behandlinger har potentielt bivirkninger; det er forskerne meget bevidste om, når de bygger nanopartiklerne. Komponenterne må ikke være toksiske i sig selv, og de vælger derfor så vidt muligt komponenter, som har været anvendt i en anden medicinsk sammenhæng, eller som i hvert fald ligner noget, man ved, er kompatibelt med det menneskelige væv.
”Mange andre grupper i verden arbejder med at udvikle sådanne partikler, så der sker virkelig meget på dette felt, og jeg er overbevist om, at det vil lykkes inden for nogle år. Om
det bliver vores partikel, der bliver den foretrukne, må tiden vise. Under alle omstændigheder er der brug for forskellige strategier til at nå T-cellerne. De kommer nemlig i mange udgaver, og det er forskelligt for hver kræftform, hvilke typer T-celler der er behov for at ramme,” siger Sine Reker Hadrup. 1
DTU DYNAMO NR. 74 09 2023 17
5 Sine Reker Hadrup, professor, DTU, sirha@dtu.dk
”Vi ser på andre mulige kræftformer, hvor det vil være relevant at bruge teknologien.”
PROFESSOR
SINE REKER HADRUP, DTU
DTU’s bud på en ny T-celleterapi bliver testet i samarbejde med Herlev Hospital i Region Hovedstaden.
Hjernemodel åbner for at teste medicin mod Parkinsons sygdom


Forskere opfinder en lille model, der efterligner den del af hjernen, der ikke virker hos parkinsonpatienter. Modellen skal øge forståelsen af Parkinsons sygdom og desuden gøre det muligt at teste nye behandlinger. Teknologien kan potentielt føre til udviklingen af et implantat.
Iet internationalt samarbejde er forskere fra DTU i gang med at skabe en hjernemodel, der efterligner det system i hjernen, der ikke virker hos parkinsonpatienter. Med modellen er det muligt at undersøge mekanismerne i sygdommen, som resulterer i, at den type dopamin, der koordinerer bevægelser og motoriske funktioner, ikke længere produceres i hjernen.
Udviklingen af hjernemodellen sker i det EU-støttede projekt OpenMIND, hvor forskere fra DTU og Lunds Universitet nu har en tidlig version af modellen på plads. Modellen består af små forskellige celleklumper af hjernevæv, der er udviklet ud fra stamceller. Til sammen repræsenterer celleklumperne det system i hjernen, som er skadet hos parkinsonpatienter.
”Modellen er bygget op, så den ligner den del af menneskets hjerne, den nigrostriatale bane, hvor doser af

18
2 Peter Aagaard Brixen
3 Thomas Steen Møller
Jenny Emnéus er professor på DTU Sundhedsteknologi og i spidsen for at udvikle en hjernemodel.
TEMA: BIOTEKNOLOGI
dopamin styrer kroppens bevægelser. I testmodellen genskaber vi med andre ord den biologiske proces, der foregår inde i hjernen, og med modellen bliver det muligt at teste og udvikle ny medicin og behandlinger. Og det er helt afgørende med en sygdom som parkinson, hvor vi ikke kan tage en biopsi i en patients hjerne uden at forårsage stor skade,” siger professor Jenny Emnéus fra DTU, der bidrager i OpenMIND-projektet med især udviklingen af hjernemodellen.
En af de behandlinger, der kan udforskes med hjernemodellen, er celleudskiftningsterapi, som kan afhjælpe rystelserne hos patienter med parkinson. Ved celleudskiftningsterapi transplanterer læger stamceller i hjernen på parkinsonpatienter, hvorefter cellerne udvikler sig, så de erstatter de ødelagte celler, der indgår i frigivelsen af dopamin. Enkelte lande i verden er begyndt at eksperimentere
med denne type behandling, heriblandt Sverige hvor læger i Lund udførte den første stamcelletransplantation på en parkinsonpatient i februar 2023.
Stamceller fra befrugtet æg
De humane stamceller, som forskerne anvender i OpenMIND-projektet, kommer fra det tidlige stadie af et kunstigt befrugtet æg, et embryo, hvor cellerne kan udvikle sig til at blive til alle celletyper i kroppen. Cellerne kaldes i medicinsk fagsprog for pluripotente stamceller. Cellerne har en evne til at dele sig uendeligt, og derfor har forskerne i princippet stamceller nok til at behandle alle parkinsonpatienter ud fra et enkelt befrugtet æg.
Det er alment kendt, at lys kan aktivere frigivelsen af dopamin, og dette udnytter forskerne, når de skal studere parkinson-mekanismerne i hjernemodellen. Det gør de ved at anvende en særlig version af de pluripotente

Om parkinson
I Danmark lever op til 12.000 mennesker med Parkinsons sygdom, og ifølge Parkinsonforeningen lever 7-10 mio. mennesker over hele jorden med sygdommen. Europa står over for en stor udfordring med en befolkning med flere ældre borgere, som vil blive ramt af neurodegenerative sygdomme.
Der er ingen kur mod Parkinsons sygdom, og eksisterende behandlinger lindrer kun symptomer. Der mangler stadig en forskningsmæssig beskrivelse af de underliggende mekanismer ved Parkinsons sygdom, bl.a. fordi eksisterende dyremodeller ikke gør det muligt at efterligne den menneskelige biologi.
stamceller, der er genetisk forandrede, så de er lysfølsomme. I hjernemodellen leveres lyset af ultratynde lyslederkabler, små optiske fibre på under 1/10 mm.
Forskerne har udviklet disse prober, der potentielt kan indopereres i hjernen. På spidserne kan der gro stamceller, som kan frigive dopamin.
Lyslederkablet i hjernemodellen er en selvstændig opfindelse, som er udviklet i samarbejde med bl.a. professor Stephan S. Keller på DTU, Lunds Universitet og Universidad Autonóma de Madrid. I projektet har forskerne udsat lyslederkablets plastikcoating for høje temperaturer, så overfladen blev omdannet til kul. Dette giver kablet en vigtig egenskab, nemlig at det bliver elektrisk ledende. På den måde kan kablet også udnyttes som en sensor til at måle dopamin og andre vigtige stoffer, der er involveret i det system i hjernen, som skal studeres.
”Forsøgene viser, at vi med lyslederkablet kan sætte gang i frigivelse af dopamin fra de omkringliggende celler og samtidig registrere, om cellerne frigiver dopamin,” forklarer Jenny Emnéus.
Potentiale for et implantat

En tredje interessant egenskab ved den forkullede overflade på lyslederkablet er, at stamceller kan gro på overfladen og udvikle sig til dopaminproducerende hjerneceller. Igen skal cellerne aktiveres ved hjælp af lys, så derfor har forskerne med en laser snittet små hak i kulstofoverfladen, så lyset kan trænge ud og stimulere frigivelse af dopamin.

DYNAMO NR. 74 09 2023 DTU 19
Til venstre ses en stor model af den struktur, der indgår i hjernemodellen. Til højre er strukturen i den rigtige størrelse og er forkullet. Det er på denne struktur i hjernemodellen, at stamcellerne gror.
Denne løsning åbner for muligheden for at udvikle teknologien til et implantat, som måske en dag kan indopereres i hjernen hos parkinsonpatienter. I dag har forskerne udviklet en første prototype, som er klar til at blive testet i dyr.

”Med et implantat kan vi potentielt behandle for parkinson præcis i den del af hjernen, hvor problemerne findes. I dag behandles patienterne med medicin, som de indtager gennem munden. Det er derfor ikke en særlig målrettet behandling, og det betyder, at hele deres hjerne bliver udsat for medicinen, og det kan give en række uønskede bivirkninger,” siger Jenny Emnéus.
Sammen med italienske og norske forskere arbejder DTU-forskerne på at udvikle en fjernbetjening, som patienterne kan bruge, efter at de har fået indsat deres implantat. Fjernbetjeningen skal kunne kontakte implantatet og aktivere lys og derved stimulere frigivelsen af dopamin, samtidig med at implantatet måler, hvor meget dopamin der frigives, når patienterne oplever symptomerne.
Hvis forskerne har succes med at udvikle systemet, så er det stadig et åbent spørgsmål, hvordan patienter skal dosere dopamin til sig selv.
”Vi forestiller os, at dopamin-doserne skal være lægeordinerede, eller at en læge på baggrund af patientens symptomer skal ordinere det interval, som dopaminen skal doseres i, så patienterne ikke sætter deres motoriske hjernecenter på konstant overarbejde,” siger Jenny Emnéus.
10 år til ny behandling
OpenMIND-forskningen er sikret finansiering frem til 2025, og forventningen er, at forskningen kan føre til udvikling af en testplatform for andre hjernenedbrydende sygdomme, i medicinsk fagsprog kaldet neurodegenerative sygdomme. Testplatformen skal bl.a. kunne udnyttes af private virksomheder, som afprøver nye typer medicin og behandling af sygdomme.
Det vil ifølge Jenny Emnéus tage mindst ti år, før forskningen kan føre til egentlige tilbud om nye behandlinger til patienter. 1

20
”Med modellen bliver det muligt at teste og udvikle ny medicin og behandlinger. Og det er helt afgørende med en sygdom som parkinson, hvor vi ikke kan tage en biopsi i en patients hjerne uden at forårsage stor skade.”
PROFESSOR JENNY EMNÉUS, DTU
TEMA: BIOTEKNOLOGI
5 Jenny Emnéus, professor, DTU, jemn@dtu.dk
Brug af bioteknologi kræver grundig omtanke
Nye bioteknologier giver os hele tiden mulighed for at gøre ting, vi ikke tidligere kunne. Men bare fordi noget er muligt, er det så også etisk ansvarligt? Sådanne dilemmaer tager institutdirektør ved DTU Fødevareinstituttet Christine Nellemann sammen med resten af Etisk Råd livtag med i et forsøg på at nuancere debatten om, hvordan vi bedst udnytter teknologiens muligheder.
Heftig debat er ikke fremmed for Christine Nellemann, som gennem sin karriere bl.a. har arbejdet på at finde alternativer til dyreforsøg og sikre den bedste udnyttelse af forsøgsdyr samt forsket i, hvor store mængder kemikalier vi mennesker kan tåle at blive udsat for via fødevarer og forbrugerprodukter.
I foråret indtrådte hun i Etisk Råd, hvor hun kan trække på netop sin erfaring med at diskutere følsomme emner, når hun sammen med resten af rådet bl.a. tager livtag med etiske spørgsmål om nye bio- og genteknologier, der berører menneskers liv samt vores natur, miljø og fødevarer.
Hvilken ballast giver din
DTU-baggrund dig?
Som institutdirektør på DTU Fødevareinstituttet har jeg i rigtig mange år arbejdet med og fået et godt indblik i, hvordan man bruger bio- og gentek-
nologi hele vejen rundt i fødevaresektoren. Jeg synes, det er utrolig interessant at få lov at bringe den erfaring ind i Etisk Råd og være med til at kigge på brugen af bio- og genteknologier inden for sundhed, natur og fødevarer.
Hvad har vi til rådighed af diagnosticerings- og behandlingsmuligheder?
Hvad kan man bruge nye teknologier til – og bør vi bruge dem? Etisk Råd er jo netop dannet for at vurdere de etiske perspektiver af teknologier og nuancere debatten.
Og der synes jeg, det er spændende, med en baggrund i et teknisk universitet, at komme med selvfølgelig
Om Det Etiske Råd
Etisk Råd er et uafhængigt og selvstændigt råd og består af 17 medlemmer, der bliver udpeget for en treårig periode. Medlemmer er en blanding af fag- og lægpersoner.
Etisk Råd blev dannet i kølvandet af det første danske reagensglasbarns fødsel i 1984, som med al tydelighed viste, hvordan en teknologisk udvikling kan flytte grænser for det mulige. Fra 2004 har nye fødevareteknologier været en del af rådets virke.
Det Etiske Råd beskæftiger sig med de etiske spørgsmål, der knytter sig til forskning i og anvendelse af bio- og genteknologier, der berører mennesker, natur, miljø og fødevarer. Det omfatter også øvrige etiske spørgsmål, der knytter sig til sundhedsvæsenet og den biologisk-medicinske forskning vedrørende mennesket.
KILDE: ETISK RÅDS WEBSITE

21 DYNAMO NR. 74 09 2023 DTU
2 Miriam Meister
3 Marie Bentzon
• Kandidatgrad i humanbiologi fra Københavns Universitet og senere ph.d. i medicin fra samme sted samt en Executive MBA fra DTU
• Forskningsfokus: giftstoffers skadelige effekter på mennesker samt alternativer til dyreforsøg
• Ansat ved DTU Fødevareinstituttet i 1999 (den daværende Fødevarestyrelse)
• Tiltrådt som DTU Fødevareinstituttets institutdirektør i 2014
• Udpeget af fødevareministeren til at sidde i Etisk Råd fra 2023 til 2026
• Bestyrelsesmedlem ved bl.a. Det Nationale Forskningscenter for Arbejdsmiljø og medlem af Danmarks Forsknings- og Innovationspolitiske Råd, DFiR
en vis teknologioptimisme, men også viden om de begrænsninger og de usikkerheder, der er ved teknologierne, og så diskutere det med folk, som sidder med mange andre baggrunde.
Som forskere stiller vi os jo sjældent frem og siger, at noget er enten sort eller hvidt – og min store erfaring med at levere forskningsbaseret rådgivning til fødevare- og miljømyndigheder har givet mig erfaring i at sige, at vi må kigge bredere end vores egen forskning og samle den tilgængelige viden, når vi skal vurdere en sag. Erfaringen med den forskningsbaserede rådgivning
og de risikovurderinger, som DTU Fødevareinstituttet leverer, giver generelt et godt grundlag for at vurdere nye teknologier.
Hvilke emner er på tegnebrættet?
Vi diskuterer lige nu de etiske perspektiver for, hvor sent i graviditeten man kan få abort uden medicinske eller sociale skærpede forhold. Hvornår er det kvindens rettigheder, som er afgørende – og hvornår skal man se på hensynet til et fosters liv? Og hvad med andre hensyn?

Vi skal også til at nuancere debatten om aktiv dødshjælp igen. Det er jo en ’Etisk Råd Classic’, men derfor er det ikke mindre relevant at bidrage til debatten endnu en gang.
Så kommer spørgsmålet om krydsfeltet mellem robotter, mennesker og kunstig intelligens, i forhold til hvordan vi vil bruge kunstig intelligens i sundhedssektoren. Hvad gør det ved os som mennesker – vores tænkning – hvis
22 TEMA: BIOTEKNOLOGI
Christine Nellemann indtrådte i foråret 2023 i Etisk Råd. Siden 2014 har hun været i spidsen for DTU Fødevareinstituttet som institutdirektør.
Om Christine Nellemann
vi f.eks. møder en kunstig intelligens i stedet for en læge?
Forsøg viser, at nogle kunstige intelligenser næsten er mere empatiske og tålmodige end en læge, og de har i hvert fald mere tid. I den kontekst er der også store spørgsmål i forhold til ansvar og transparens – og her vil vi nok komme til at arbejde sammen med Dataetisk Råd.
Der er også hele den grønne omstilling – som jo er et område, jeg taler kraftigt for – hvor Etisk Råd netop er udkommet med en rapport om de etiske aspekter ved nye fødevareteknologier, som kan accelerere omstillingen.
Grundlæggende skal vi holde fast i, at en fødevare kun er en fødevare, hvis vi kan spise den uden at blive syge, og vi får god ernæring fra den. Men derudover bliver der brug for etiske afvejninger i forhold til produktionen, så den grønne omstilling bliver kraftig nok til virkelig at blive til gavn for mennesker. Vil vi f.eks. spise bøffer, der er dyrket i laboratoriet med stamceller fra en ko, eller kun bøffer, der er skåret ud af koen?
Er alt til debat – eller findes der hellige køer?
I Etisk Råd er alt til debat, og jeg synes, vores formand sørger for at skabe et miljø, der lægger op til, at alt kan diskuteres. For det har utrolig meget at gøre med, hvordan stemningen er, om man har mod på at stille nogle af de mere kontroversielle eller provokerende spørgsmål.
Det er jo også sådan nogle fora, vi gerne skal kunne have på universiteterne og i samfundet generelt. Hvor vi finder tiden til at lytte og diskutere komplicerede emner sammen.
Jeg har siddet i en EU-ekspertgruppe, som skulle kigge på den grønne omstilling af fødevaresystemet i EU. Her sagde nogle af forskerne,
’jamen nu synes vi, at vi har råbt op så længe, og politikerne hører ikke efter’, så de fik lyst til at blive mere agiterende i stedet for at stå på den rent forskningsmæssige viden i et håb om at få politikerne til at handle.
Men det er ikke den vej, vi skal gå, for det er ikke fordrende for den åbne samtale. Den åbne samtale kan dog være svær at tage i det helt store rum, og det er derfor, vi har brug for steder som Etisk Råd, som er sat i verden for at tale og reflektere og have dialogen over længere tid.
Jeg synes, det kunne være rigtig spændende, hvis vi kunne få den samtale i gang på forskellige niveauer, men det kræver først og fremmest et trygt rum, som man kan brede samtalen ud fra.
Hvordan balancerer du mellem fakta og følelser? Som medlem i Etisk Råd bliver vi faktisk på møderne bedt om at fremlægge argumenter og vurderinger og ikke holdninger som sådan. Så ender man ud med at gøre sin holdning klar til sidst, når rådet kommer med en officiel betragtning, og medlemmerne beslutter, hvordan de personligt vil forholde sig til den – og det bliver offentliggjort med navns nævnelse. Målet er at inddrage alle mulige fakta og sider af sagen og vende dem i dialogen. Min oplevelse er, at ens holdning kan ændre sig undervejs. Så nok kan man starte med at have en mavefornemmelse om et emne. Men når man har hørt alle indlæg, læst rappor-
terne og diskuteret det, så er en del af medlemmerne faktisk blevet rykket, i forhold til hvad de oprindeligt rent intuitivt mente.
Gode ting tager tid – men tager Etisk Råd sig for god tid?

Vi diskuterer faktisk, om vi kunne blive lidt mere aktuelle, lidt på forkant, så vi kan melde ud om forskellige emner hurtigere. Når det er sagt, er det jo et privilegium, at vi kan kigge på ting i halve eller hele år og diskutere og få input fra rigtig mange sider og udvikle og modne vores vurderinger – i modsætning til f.eks. politikere, som kan blive stoppet af radioen om morgenen for at udtale sig om, hvad de mener om abortgrænser eller noget helt andet.
Faktum er jo, at den teknologiske udvikling er rigtig hurtig på mange forskellige felter. Og der synes jeg, at Etisk Råd giver mig personligt muligheden for at stoppe op og være mere reflekterende og nysgerrig på, hvad andre tænker. Det synes jeg er meget værdifuldt og noget, som jeg rent personligt også får en del ud af. 1
5 Christine Nellemann, institutdirektør, DTU, clne@food.dtu.dk
DYNAMO NR. 74 09 2023 23 DTU
”Jeg synes, det kunne være rigtig spændende, hvis vi kunne få den (åbne, red.) samtale i gang på forskellige niveauer, men det kræver først og fremmest et trygt rum, som man kan brede samtalen ud fra.”
CHRISTINE NELLEMANN, DTU


DTU 24 KIG MED DYNAMO NR. 74 09 2023
Små ål sættes ud i dansk natur

I løbet af sensommeren blev

1.682.000 små ål udsat i danske vandløb, søer og kystnære områder. På fotoet ses åleudsætning i Esrum Sø, hvor Benny Østergaard var en af de fem frivillige fra Esrum Ålaug, der sejlede ud på søen for at fordele de i alt 50.000 ål, der skulle udsættes dér.
Glasålene, som de kaldes, når de er små, blev fisket op i sydfranske floddeltaer i marts. Efter fangst blev ålene fragtet til danske dambrug, hvor de er vokset til en størrelse på knap 15 cm og en vægt på mellem 2 og 5 gram.
Der udsættes ål i Danmark hvert år. Formålet er at genoprette bestanden af blankål, som de voksne ål kaldes. Indsatsen er en del af en europæisk genopretningsplan, som finansieres af EU og Fiskeristyrelsen, og i Danmark koordineres udsætningen af DTU Aqua.
Ved udsætning er ålene mellem 1-2 år gamle, hvorefter de bruger 5-15 år på at blive voksne. Til den tid forlader de opvækstområderne og svømmer helt til Sargassohavet, som er et havområde i det vestlige Atlanterhav ca. 6.000 km fra Danmark.
Her gyder ålene, hvorefter deres larveyngel bliver ført af havstrømmene tilbage til opvækstområderne i Europa. Mængden af yngel, som ankommer med havstrømmene, er historisk lav, og ålen er i dag angivet som en kritisk truet art.
DTU 25 3 MIKAL SCHLOSSER 2 LOTTE KRULL
5 Michael Ingemann Pedersen, videnskabelig medarbejder, DTU, mip@aqua.dtu.dk
NY OG EFFEKTIV METODE:
SÅDAN OMDANNES SUKKER TIL KLIMAVENLIG PLASTIK
Sukker udtrukket af majs, sukkerroer og halm er fremtidens råprodukt til fremstilling af plastik. Virksomheden Topsoe er på vej med en ny teknologi, som inden for få år vil reducere plastikkens CO2-aftryk.


Når vi tænker på plastik, tænker vi også på fossil olie. For plastik er produceret på basis af undergrundens råstof, hvorfra vi bl.a. udvinder grundstoffet karbon (kulstof), som udgør en væsentlig ingrediens i plastik. Omkring 5-6 pct. af al den råolie, der pumpes op fra undergrunden, indgår i dag i forskellige plastprodukter.
Men sådan behøver det ikke at være i fremtiden. Med ny teknologi kan biomasse bruges som alternativ til fossile råstoffer til fremstilling af plastik. Ved at erstatte råolie med biomasse kan vi sikre væsentlige reduktioner i plastikkens CO2-udledning.
Virksomheden Topsoe (fhv. Haldor Topsøe), der leverer teknologi til grøn
omstilling af bl.a. kemikalie- og brændstofproduktionen, er sammen med DTU i fuld gang med at udvikle den biomassebaserede metode til at fremstille en af komponenterne, som indgår i produktionen af PET-plastik. Det er en af de mest anvendte plasttyper, som bl.a. bruges til at lave sodavandsflasker og anden fødevareemballage samt til at fremstille polyesterfibre til tøj og tæpper.
”Målet er at tage sukker og omdanne det hele vejen til ethylenglykol, som er en af byggestenene til at lave PETplastik,” fortæller Esben Taarning, udviklingsleder for biobaserede kemikalier hos Topsoe.
Proces i to trin
At omdanne sukker til ethylenglykol er ikke nyt. Teknologien er dog ikke særlig effektiv og kan ikke konkurrere med produktion baseret på råolie.
”Med den metode mister man meget af kulstoffet undervejs. Målet med vores projekt er at bibeholde så stor en del som muligt af kulstoffet, der er i sukkeret, og bringe det over i ethylenglykol-molekylet. Vi kan på den måde få et meget større udbytte ud af sukkeret,” forklarer Esben Taarning.
2 Henrik Olsen
3 Thomas Steen Sørensen, Claus Lunau
26 GRØN OMSTILLING
Processen, som Topsoe har udviklet, foregår i to trin. Først varmer man en vandig sukkeropløsning op i en reaktor. Opvarmningen fra stuetemperatur til 500-600 grader medfører en såkaldt sukkerkrakning – en spaltning af sukkermolekyler til mindre molekyler. Hovedproduktet i denne
Esben Taarning, R&D director hos Topsoe (tv.) og professor Anker Degn Jensen fra DTU har gennem flere år samarbejdet om en ny og mere effektiv proces, der udnytter biomasse til fremstilling af PET-plastik.
krakningsreaktion er glykolaldehyd. Andet trin er en såkaldt hydrogenering, hvor glykolaldehyd bliver tilføjet brint (hydrogen), hvilket fører til dannelsen af det vigtige plastråstof ethylenglykol.


Ifølge Esben Taarning er det den første del af processen, hvor sukkermolekylerne brydes ned i mindre dele,
PET (polyethylenterephthalat)
PET-plastik fremstilles af to råstoffer: ethylenglykol, som udgør 30 pct., og terephthalsyre, som udgør 70 pct. af det færdige plastprodukt.
PET er en af de mest anvendte typer af plastik i europæisk emballageindustri. Det skyldes materialets styrke og stivhed, der betyder, at det kan tåle højt tryk og modstå slag, samtidig med at det er varmestabilt og har særdeles gode barriereegenskaber over for vand, CO2, ilt og kvælstof.
KILDER: ESBEN TAARNING, PLASTINDUSTRIEN
der er det banebrydende ved anlægget. Og det er netop dette procestrin, DTU Kemiteknik har deltaget i. Professor Anker Degn Jensen har været involveret lige fra begyndelsen i 2017.
”I den første del af projektet var DTU med til at udvikle teknologien, så den kunne opskaleres fra laboratorieskala til
DTU DYNAMO NR. 74 09 2023 27
en større skala. Her var målet at gå fra laboratoriets reaktor i centimeterskala til på et tidspunkt at nå frem til en reaktorstørrelse på en meter i diameter og en kapacitet på mange hundrede tusind ton sukker om året,” fortæller Anker Degn Jensen.
Teknologiens hemmelighed
Den reaktor, som anvendes til sukkerkrakningen, kan på mindre end ét sekund varme sukkeropløsningen op til 500-600 grader. Og denne lynopvarmning er altafgørende. Hvis opvarmningen sker for langsomt, bliver karamel dannet undervejs i processen. Og karamel skal man for alt i verden undgå, for det klistrede stads sviner reaktoren til – og det er desuden umu-
ligt at omdanne karamelmassen til det ønskede stof, glykolaldehyd.
Hemmeligheden bag teknologien er en såkaldt fluid bed-proces. Inde i reaktorkammeret tilføres der konstant et 500-600 grader varmt keramisk pulver. Pulveret løftes op i reaktoren af en sukkeropløsning i gasform, som blæses ind. Denne strøm af ’sukkergas’ får det keramiske pulver til at opføre sig som en væske. Det kaldes for fluidisering, og det skaber en god og jævn kontakt mellem sukkeropløsningen og det keramiske pulver. Dermed sikrer man en effektiv lynopvarmning af sukkeret, så man opnår den ønskede krakning til glykolaldehyd.
Kold reaktor
Der, hvor sukkeropløsningen blæses ind over det varme pulver, er et meget kritisk sted i processen, fortæller Anker Degn Jensen.
For bedre at kunne studere denne kritiske proces har DTU Kemiteknik bygget en modificeret udgave af reaktoren, der opererer under kolde betingelser. Her er alle reaktorens dele konstrueret i gennemsigtig plastik, så

man kan se ind i selve reaktoren. Og cirkulering af det faste stof – det keramiske pulver – sker ved stuetemperatur i stedet for 500-600 grader.
”Ved at observere pulverets cirkulation i reaktoren og samtidig følge sammenhængen mellem koncentrationen af pulveret forskellige steder i opstillingen som funktion af tilførslen af mængden af gas har vi fået en langt bedre forståelse af processen,” forklarer professoren.
Dette studie blev udført som et postdocprojekt i samarbejde med DTU Kemitekniks værksted, der har bygget reaktoren. Derudover er to ph.d.-studier gennemført, som har fokuseret på henholdsvis kemiske reaktioner ved anvendelse af forskellige pulvertyper og computerberegning af de processer, som foregår inde i reaktoren.
I den nuværende fase af projektet ser DTU mere detaljeret på sukkerkrakningen. Et postdocstudie tester forskellige materialer til brug som pulver i reaktoren for at analysere, om det er muligt at få processen til at foregå ved lavere temperaturer.
Længe undervejs
Udviklingen af den nye teknologi har været længe undervejs. Den tog sin spæde start i 2010 i form af et ph.d.-projekt på Topsoe, hvor en lille testreaktor i laboratorieskala blev bygget for at undersøge konceptet. Resultaterne var lovende, og i 2017 fik Topsoe sammen med DTU en bevilling på 30 mio. kr. fra Innovationsfonden til en opskalering af processen ved at bygge et pilotanlæg til produktion af ethylen-
28 GRØN OMSTILLING
Slutproduktet er PET-plastik som disse granulater.
”Vi håber, at det
første anlæg kan starte op i 2026.
Det vil være vildt.”
R&D DIRECTOR ESBEN TAARNING, TOPSOE
glykol. Pilotanlægget kan behandle omkring 50 kg sukkermasse i timen.
Et kommercielt produktionsanlæg skal skaleres mindst 500 gange op.
I 2021 fik Topsoe sammen med DTU, Nordic Sugar A/S og University of Western Ontario yderligere 18,6 mio. kr. i støtte fra Innovationsfonden til at eksperimentere med reaktoren og selve processen for at optimere produktionen.
Slutmålet for Topsoe er at vise, at processen fra sukker til ethylenglykol kan opskaleres til egentlig industripro-
duktion. Esben Taarning er optimistisk, men også lidt spændt.
”Vi håber, at det første anlæg kan starte op i 2026. Det vil være vildt,” siger han.
Og aftageren er allerede klar i kulissen. Et joint venture mellem verdens største bioplastikproducent, Braskem, og det japanske industrikonglomerat Sojitz har meldt sig klar til at købe en licens til at bygge det første kommercielle anlæg, når teknologien er på plads.
Dette sker i reaktoren
1. Keramisk pulver varmes op til 500-600 grader og føres op i reaktoren.
2. Sukkeropløsning på væskeform blæses ind.
3. Sukker krakkes (spaltes) til glykolaldehyd ved kontakt med det varme keramiske pulver.
4. Glykolaldehyd separeres fra pulveret.
5. Fastbrændte kulpartikler fjernes.
6. Renset keramisk pulver føres tilbage.
7. Glykolaldehyd kan efterfølgende omdannes til ethylenglykol, som bruges til at fremstille PET-plastik.
Det er et stort marked, man til den tid træder ind på. Der produceres årligt omkring 30 mio. ton ethylenglykol på verdensplan, og CO2-aftrykket er betydeligt. Med den nye sukkerbaserede teknologi regner Esben Taarning med, at man vil være i stand til at reducere CO2-belastningen til det halve af den nuværende fossile belastning. 1

1 2 3 4 7 5 DTU DYNAMO NR. 74 09 2023 29
6
5 Anker Degn Jensen, professor, DTU, aj@kt.dtu.dk
HVORFOR ER DER MODSTAND MOD VINDMØLLER OG SOLCELLER?
Vindmøller, solceller og snart Power-to-X-anlæg opsættes overalt i det danske land, men de store anlæg bliver ikke altid godt modtaget af de lokale. Det kan bremse den grønne omstilling, og det er et underbelyst emne i forskningen, ifølge lektor Julia Kirch Kirkegaard fra DTU Wind.
q: Hvornår opstår der typisk lokal modstand mod store anlæg til grøn omstilling?
a: Det opstår typisk i planlægningsfasen, når der inviteres til borgermøder, eller projektet bliver annonceret. Det sker, fordi folk efterhånden har en meget stor mistillid til, hvordan processerne foregår, og de lokale føler ikke, de bliver inddraget nok. Man kan ikke sætte vindmøller eller solcelleparker op, medmindre man har en kontrakt med en lodsejer og har adgang til jorden, og Danmark er jo et lille land, så der er kamp om pladsen. Det betyder, at der sker en masse hemmelige aftaler mellem projektudviklere og lodsejere, og folk føler, at de bliver ført bag lyset, og der faktisk er minimal mulighed for at påvirke processen. Det bliver
spil for galleriet, hvis beslutningen allerede er truffet.
q: Så det handler om mere, end at folk synes, at det er grimt at se på?
a: Det er meget sjældent, at det bunder i, at det er grimt eller støjer for meget. Ofte er det følelsen af at blive tromlet hen over og ikke få en reel chance for at få indflydelse. Derudover giver de store projekter sjældent værdi tilbage til lokalsamfundet.
q: Hvad bunder modstanden i?
a: Når man ser på det historisk, så bunder noget af modstanden i, at der har været så stor en teknologisk udvikling, hvor vindmøllerne er blevet enormt store og utroligt dyre. I 70’erne og 80’erne opstod der små, lokale andelslav, der
opførte små vindmøller. Det var ofte lokale bønder, der gik sammen med højskolefolk og bankede nogle vindmøller op, og så tjente de lidt på det. Men i dag har udviklingen skubbet de små aktører ud, og i stedet er det store, internationale virksomheder med mange penge på kistebunden, der bygger og opsætter vindmøller. Det er ikke, fordi vi skal gå tilbage til de gamle andelsdage, men det er værd at diskutere, om man kan få skabt noget lokalt medejerskab på en eller anden måde.
q: Hvor stort er problemet?
a: Siden 2001 har man oplevet stigende modstand, og i 2022 blev der nærmest ikke stillet nogen vindmøller op på land. Tal fra Energistyrelsen har vist, at siden 2009 er hvert femte vindmølleprojekt på
land blevet droppet på grund af borgerprotester. Klimaminister Lars Aagaard har også sagt, at vi ikke når vores klimamål – bl.a. målet om at firedoble sol- og vindenergi på land – hvis vi ikke får løst det her problem.
q: I den nærmeste fremtid skal der opføres energiøer og Power-to-X-anlæg rundtom i Danmark.
Hvordan tror du, borgerne vil tage imod dem?
a: Det er ret vildt, hvor meget Power-to-X-anlæg kommer til at fylde, og jeg tror ikke, det er gået op for folk endnu, at det ret drastisk kommer til at ændre, hvordan Danmark ser ud. Jeg talte med en lokal planlægger i Jylland, der fortalte, at der skal opføres anlæg på størrelse med 2.000 fodboldbaner, og det
2 Sole Bugge Møller
3 Frida Gregersen
30 HVAD GØR VI MED VINDMØLLEMODSTAND? DYNAMO SPØRGER
Julia Kirch Kirkegaard er lektor på DTU Wind og har været med til at etablere en multidisciplinær sektion, som skal klæde ingeniører bedre på til at forstå den komplekse virkelighed, som møder teknologierne i den grønne omstilling.
er jo en reindustrialisering af det danske landskab. Så borgerprotesterne er ikke et problem, der bliver mindre lige foreløbig.
q: Hvad er løsningen?
a: Der er desværre ikke nogen ’silver bullet’, der kan fikse det hele. Men der er brug for en uvildig aktør i processen, der ikke bliver anklaget for at have en skjult agenda. Energistyrelsen har for nylig genoprettet et rejsehold for vedvarende energi, der skal tage rundt og hjælpe kommunerne, som jo sidder med meget af ansvaret for, hvad der skal udvikles på land, og bøvler med den lokale modstand. Det kan være en start til at sætte en anden slags borgermøder op.
Man bliver nødt til også at kigge på, hvordan man
designer udbudssystemet, så der er plads til projekter, som ikke er storskala, men faktisk skaber en anden form for værdi end blot økonomisk. Nogle projekter kan måske konkurrere på at give noget tilbage til lokalsamfundet, samtidig med at borgerne føler, at de er involveret og med til at gøre en forskel i den grønne omstilling. Man kan også lave en form for medejerskab, så de lokale får del i overskuddet, eller der oprettes en lokal fond.
q: Må folk give nogle afkald i den gode sags tjeneste, hvis vi skal i mål med den grønne omstilling?
a: Der er ingen tvivl om, at der er behov for, at tingene går hurtigt, og at vi også har behov for de større vindmølleparker, men folk
accepterer ikke bare at få et hold kæft-bolsje og en kompensation. Der skal stadig være plads til de lokales engagement og reel inddragelse. Hvis vi bare kaster teknologien efter borgerne og beder dem om at acceptere det, så kommer modstanden tilbage som en boomerang. Så vi bliver nødt til at tænke innovativt og tage kommunikationsopgaven meget seriøst –det går ikke bare at sige ’vi er eksperterne, så vi ved bedst’. Ellers har vi ikke set toppen af modstanden endnu.
• Lektor på DTU Wind med en baggrund i bl.a. organisationssociologi og Science & Technology Studies.
• Har for nylig udgivet en artikel i Nature Energy, der bringer et samfundsfagligt perspektiv på de store udfordringer inden for vindenergi.

• Har været central i etableringen af en ny multidisciplinær sektion siden sin ansættelse på DTU i 2015. I 2020 blev Section for Society, Market & Policy (SMP) på DTU Wind etableret med forskere fra felter som sociologi, antropologi, geografi og økonomi for bedre at forstå transitionen til vedvarende energi.
• Principal Investigator i Co-Green-projektet om kontroverser om vindmøllestøj.
• Har netop modtaget en bevilling på 11 millioner kr. fra European Research Council til at undersøge, hvordan man kan inkludere alternative former for ekspertise i designfasen med Energiø Bornholm som case.
5 Julia Kirch Kirkegaard, lektor, DTU, jukk@dtu.dk
Julia Kirch Kirkegaard
DTU DYNAMO NR. 74 09 2023 31
3D-SKANNINGER UDFOLDER GULDSKATTENS HEMMELIGHEDER


En af danmarkshistoriens største guldskatte er blevet 3D-skannet på DTU. Forskere forsøger nu at folde guldet ud digitalt og nå ind til ny viden om jernalderens magtdynastier.
er dateret til at være gravet ned i 500tallet, og fundet er af eksperter blevet vurderet til at være på højde med Guldhornene.
Kamerafolk og journalister fra BBC, TV 2 og DR stod på spring, da en pansret pengetransport den 10. februar 2022 kørte op og standsede foran DTU’s Imaging Center. Alle havde de linsen rettet mod den brune skotøjsæske, som Nationalmuseets arkæolog forsigtigt bar ud af pengetransporten og ind gennem Imaging Centrets svingdør.
I skotøjsæsken lå nemlig verdens største guldbrakteat. Brakteaten, der er et medaljonlignende halssmykke på 13,5 cm, blev sammen med 15 andre brakteater og fire romerske medaljoner fundet af en amatørarkæolog et år tidligere på en mark ved den østjyske by Vindelev. De i alt 794 gram guld
Der er dog et problem: Mange af brakteaterne er foldet så meget sammen, at arkæologerne ikke kan aflæse de motiver og runeinskriptioner, der er i guldet. Det er for risikabelt at folde guldet ud med håndkraft, da det risikerer at knække, og derfor har Nationalmuseet og VejleMuseerne søgt hjælp fra moderne teknologi på DTU.
”Nogle gange kan teknologien åbne døre, som vi ellers ikke har adgang til. I dette tilfælde vil vi gerne kunne se inskriptionerne og billederne på brakteaterne bedre, så vi kan blive klogere på stormanden, der ejede skatten. Hvad var hans magt? Hvad var hans domæne? Hvis det lykkes, vil det være med til at give os et bedre billede af,
hvordan samfundet i 400-500-tallet var stykket sammen,” siger Mads Ravn, der er arkæolog og forskningschef på VejleMuseerne.
Teknologien, Mads Ravn håber på kan give nye svar, er kendt fra hospitalsverdenen som CT-skanning. Her bruges CT-skanneren til at give detaljerede røntgenbilleder af en patients indre organer. I nyere tid er samme teknologi dog også blevet brugt af fysikere til at skanne materielle genstande og genskabe dem som digitale

32 IMAGING
2 Sari Vegendal
3 Mikal Schlosser, Konserveringscenter Vejle, DTU
3D-rekonstruktioner. På DTU har man f.eks. skannet og rekonstrueret et 66 mio. år gammelt Tyrannosaurus rex-kranie.


Da brakteaterne fra Nationalmuseet tilbage i februar 2022 passerede svingdøren til DTU’s Imaging Center, var det dog ikke ’kun’ for at blive skannet og rekonstrueret. De skulle også foldes ud digitalt. Efter endt skanning stod DTU’s forskere således tilbage med en sammenfoldet fortidsgåde og 9.600 skanningsbilleder til at løse den.
Tykkelse på guldet giver problemer
I arbejdet med at løse gåden har varierende tykkelser på guldet vist sig at skabe udfordringer. De steder, hvor brakteaternes guld er tyndt på grund af stempeltryk og indgraveringer, er der på skanningerne opstået det, man på fagsprog kalder for artefakter. Altså uoverensstemmelser mellem den virkelige brakteat og resultatet af skanningen. Og det kommer til udtryk rent visuelt.
”På hospitalerne ser man artefakter, når man f.eks. skal CT-skanne en patient, der har fået opereret skruer ind i benet. Så giver det sådan nogle streger på skanningen, og det samme har været tilfældet her. Vi har fået en hel masse streger, og det ville vi ikke have fået, hvis tykkelsen på brakteaterne havde været den samme overalt,” forklarer seniorforskningsingeniør ved DTU Fysik Carsten Gundlach. Han har brugt data fra de hundredvis af skanningsbilleder, der er taget

DTU DYNAMO NR. 74 09 2023 33
En brakteat gøres klar til at blive CT-skannet i DTU’s Imaging Center i et forsøg på at løse mysteriet om, hvorfor Vindelevskattens genstande var bøjede.
360 grader rundt om hver enkelt brakteat, til at regne sig frem til de rumlige 3D-billeder. Det har med Carsten Gundlachs egne ord resulteret i ”nogle fornuftige” 3D-rekonstruktioner af brakteaterne, når de er sammenfoldede. Men når hans kollega fra DTU Compute Hans Martin Kjer forsøger at lave en udfoldet version, giver artefakterne problemer.
”Vi har bl.a. forsøgt at udfolde en af de mindre brakteater, kaldet X17, men det er svært for os at definere, hvor kanten på brakteaten er, og hvor den præcise skillelinje mellem to flader befinder sig. Når der er mange, tætte sammenfoldninger på guldet, betyder det, at vi har svært ved at adskille overfladerne fra hinanden. I sidste ende gør det det meget svært at lave en perfekt udfoldning, hvor man kan se alle detaljerne,” forklarer Hans Martin Kjer.
Det har dog ikke fået de to forskere til at give op. Ud fra samtaler med arkæologerne har de sporet sig ind på, hvilke motiver der har en særlig historisk interesse. Fokus har herefter rykket sig fra hele brakteaten til en udfoldning af de enkeltdele, der kan give arkæologerne ny viden om Danmark i 400-500-tallet.
Skat kan have skiftet hænder Spørger man arkæolog Mads Ravn, kan Danmark på fundenes tid bedst
En sammenfatning af en 3D-rekonstruktion af brakteaten X17, som den ser ud sammenfoldet. De hvide streger er artefakter forårsaget af varierende tykkelser på guldet.




beskrives som det, romerne kaldte ’det vilde Germanien’. Her regerede enevældige klanledere på afgrænsede territorier ud fra samme logik, som man kender det fra rocker- eller mafiagrupperinger i dag.
”Jo flere krige de vandt, jo stærkere blev de som klanledere. Og jo mere guld og rigdom de kunne skaffe til deres følgere, jo flere følgere fik de,” siger Mads Ravn.
At dømme ud fra størrelsen på Vindelevskatten mener han, at dens ejermand må have været en særdeles magtfuld klanleder, man ikke før har kendt til. Det giver findestedet
Et af forskernes første resultater, udfoldningen af X17, viser, at dele af brakteaten kan udfoldes til en vis grad. Grundet artefakter på skanningen er det dog svært at genskabe alle medaljonens kanter og skillelinjer.
omkring Vindelev, der ligger 8 km øst for Danmarks vugge, Jelling, en ny og betydningsfuld status som magtcentrum. Samtidig har Vindelevskatten en tæt lighed med tidligere guldfund ved byen Gudme på Fyn, der anses for at være Danmarks vigtigste magtcentrum fra 200- til 500-tallet. Det får arkæologerne til at tro, at nogle af brakteaterne fra Vindelev kan være lavet af en smed i Gudme, og hvis det er tilfældet, må guldet på et tidspunkt have skiftet hænder.
Teorien er derfor, at der har været en tæt forbindelse – måske en alliance –mellem klanlederne af de to magtcentre.
34 IMAGING
DTU seniorforskningsingeniør Carsten Gundlach fremviser et skanningsbillede af en sammenkrøllet brakteat fra Vindelevskatten.
”Det er muligt, at guldet er blevet givet som gave i forbindelse med et ægteskab mellem klanernes døtre og sønner,” siger Mads Ravn.
For at kunne drage mere præcise konklusioner er Mads Ravn særligt interesseret i at se motiverne på den største af guldbrakteaterne, hvor det ligner, at der i midten gemmer sig et sammenfoldet tvillingemotiv, mens stemplerne omkring også kan sige noget om brakteatens ophav og alder.
Viser de sig at være stempelidentiske med Gudmefundene, er smeden bag de to skatte den samme, og arkæologerne kan gå videre med teorien om den tætte forbindelse mellem Vindelev og Gudme.
”Det er lidt ligesom en retssag, hvor jo flere indicier vi indhenter, jo stærkere bliver argumentet. Vi kan jo ikke bare spørge de mennesker, der levede dengang. Vi er afhængige af de indirekte beviser, og det er det, DTU kan hjælpe os med,” forklarer Mads Ravn.
”Forskningen stopper aldrig”
I den digitale skattejagt på svar er DTU’s forskere kommet tættere på beviserne end tidligere. Det er nemlig lykkedes dem at udfolde et afgrænset område med færre foldninger på en af skattens mindre brakteater, kaldet X19.
”Det er et noget bedre resultat, end da vi prøvede at udfolde hele brakteaten. Med den her metode kan vi optimere på de enkelte områder,” siger Carsten Gundlach. Han mener dog, at resultaterne kan blive bedre, men hæfter sig ved, at der er et potentiale, som er værd at gå videre med.
”Metoden lukker op for muligheden for, at man på sigt kan tage de enkelte dele og stykke dem sammen, efterhånden som de foldes ud,” siger han.

På VejleMuseerne vækker det nye resultat også begejstring. Både fordi metoden, der er brugt, kan give ny
indsigt i jernalderens magtdynastier, og fordi den måske kan hjælpe arkæologerne med at afgøre, hvorfor nogle af brakteaterne ser ud til at være foldet sammen med håndkraft, mens andre er mere kantede og sandsynligvis er blevet ødelagt århundreder efter nedgravningen af en moderne plov.
”Det kunne være interessant at få set nærmere på, om DTU kan skelne mellem de tilfældigt ødelagte brakteater og de bevidst bøjede ud fra de matematiske algoritmer, der allerede arbejdes med. Man kunne forvente, at der for de bevidst ødelagte er en større systematik og symmetri,” siger Mads Ravn. Han forklarer, at hvis klanlederen selv har bøjet brakteaterne sammen, sandsynliggør det, at skatten har været en ofring til guderne.

Næste skridt er først og fremmest at folde tvillingemotivet og stemplerne ud på verdens største brakteat.
DTU-forskerne håber på, at arbejdet med skatten kan lukke op for en ny portefølje af samarbejder med arkæologer og museumsfolk. Men hvornår målet er nået, og forskerne er tilfredse, står lige så ubesvaret hen som mange af de gåder, der fortsat omgærder Vindelevskatten.
”Der er stadig mange udfordringer, og det er selvfølgelig irriterende, at man ikke bare kan få afsluttet tingene og komme videre. Men der er altid mere, man kan gøre,” siger Hans Martin Kjer og tilføjer: ”Forskningen stopper aldrig.” 1
5 Carsten Gundlach, seniorforskningsingeniør, DTU, cagu@fysik.dtu.dk
En 3D-visualisering fra rekonstruktionen af brakteaten X19. Den røde flade viser det specifikke område, forskerne har fokuseret på at folde ud. Hullerne illustrerer, hvor der på grund af guldets tykkelse er opstået artefakter.
Her ses overfladen foldet ud. Forskernes udfoldning afslører et motiv af en mand i midten af brakteaten, som ifølge arkæologerne meget vel kan være en romersk kejser. Oldtidens danskere kopierede portrætterne af Romerrigets kejsere i f.eks. deres smykker og tilføjede deres egne symboler i portrættet.

DTU DYNAMO NR. 74 09 2023 35
Studerende er oppe på lakridserne i indretning af fabrik
Fem studerende fra DTU har udviklet et forslag til, hvordan Bagsværd Lakrids’ fabrik kan indrettes, så både produktionskapaciteten og arbejdsglæden bliver større.
Det summer af aktivitet bag de store glasvinduer i nr. 119 og nr. 123 på Bagsværd Hovedgade en sommerdag i 2023. En plantegning ligger på et bord midt i det store lokale, der i efteråret 2023 føjes til den eksisterende lakridsfabrik Bagsværd Lakrids. Med plantegningen præsenterer fem DTU-studerende deres forslag til fabrikkens nye indretning for lakridsfabrikkens direktør, Morten Kornbech Larsen.

På 13 uger har Agnete Terkelsen, Emil Fossdahl Hecht-Nielsen, Emil Lynge Rasmussen, Stefan Perovic og Amanda Rosgaard, der alle er ved at uddanne sig til civilingeniører i Design og Innovation på DTU, udarbejdet forslaget, der skal løse flere indretningsmæssige udfordringer. Det skal både sikre, at produktionskapaciteten øges, og at arbejdsglæden hos de ansatte bliver større. Desuden skal lakridsfabrikken fortsat kunne fremvise sin lakridsproduktion for både besøgende og for forbipasserende ude på hovedgaden.
Den nuværende fabrik ligger lige ved siden af det nye lokale – faktisk så tæt,
36 SAMARBEJDE
2 Linnea Lundberg
3 Magnus Møller
Agnete Terkelsen (til venstre) og Amanda Rosgaard har sammen med tre andre DTU-studerende udarbejdet et forslag til, hvordan Bagsværd Lakrids’ skal indrette deres fabrik.
at der bliver fri passage mellem dem, hvis blot man river en væg ned. Og det er netop en af de ting, som efter planen skal ske.
Ud fra plantegningen diskuterer de fem studerende og Morten Kornbech
Larsen ivrigt fordelene og ulemperne ved enten at indrette de to lokaler som to mindre fabrikker eller ved at samle hele produktionen i én stor fabrik. Et argument for at have de store gryder med den skoldhede lakridsmasse fordelt i to minifabrikker lyder, at så kan flest mulige kunder og forbipasserende få indblik i, hvordan man laver lakrids på gammeldags manér.
Samler man derimod produktionen i en stor fabrik, vil det nye lokale primært blive brugt til at skære lakridsmassen ud og pakke den, mens man holder alle gryderne samlet i det gamle lokale. Fordelen ved denne løsning er, at det gør det let for medarbejderne at fordele dagens opgaver, fordi hver del af produktionen (fremstilling, udskæring, pakning osv.) har sit eget område.
Alle omkring bordet og plantegningen er dog enige om, at den bedste løsning er den, der skaber mest muligt flow i arbejdsgangene, så man undgår flaskehalse i produktionen uden at gå på kompromis med medarbejdernes arbejdsglæde.
Handlinger frem for ord
De fem studerende har udarbejdet deres bud på indretningen på kurset Brugerinvolveret Systemdesign, der er en fast del af bacheloruddannelsen i Design og Innovation. Som led i undervisningen skal de studerende først finde og så samarbejde med en virksomhed om at afprøve nye måder at designe systemer eller i dette tilfælde en fabrik.

Amanda Rosgaard arbejdede i forvejen hos Bagsværd Lakrids, da hun og hendes medstuderende blev præsenteret for opgaven at finde en virksomhed, og hun vidste også, at lakridsfabrikken snart skulle udvides. Derfor spurgte hun Morten Kornbech Larsen, om Bagsværd Lakrids var interesseret i at indgå et samarbejde, og svaret var ja.
”Samarbejdet med Bagsværd Lakrids har givet os mulighed for at bruge de
modeller, vi har lært om på kurset, i den virkelige verden sammen med en rigtig virksomhed, og det har været enormt lærerigt,” forklarer Amanda Rosgaard.
De studerendes forslag til indretningen er især baseret på det, der kaldes for kontekstuelle interviews med Bagsværd Lakrids’ medarbejdere. Et kontekstuelt interview foregår i den kontekst, der er relevant for interviewets emne.
”Vi har kort sagt set mere på, hvad medarbejderne rent faktisk gør i løbet af en arbejdsdag, end vi har analyseret, hvad de siger, at de gør. Ved at benytte denne metode har vi sikret os, at vores bud på indretningen af den nye fabrik passer sammen med de ansattes arbejdsgange i den nuværende fabrik der, hvor det fungerer, og forbedrer dem der, hvor de kan forbedres,” forklarer Agnete Terkelsen.
Tid til en grundig analyse
For Morten Kornbech Larsen er udbyttet af samarbejdet med de fem DTU-studerende stort:
”De udfordrer mit perspektiv, fordi de i modsætning til mig ser på arbejdsgangene i vores fabrik med helt nye øjne, og samtidig har de tid til at lave en langt grundigere analyse, end jeg har,” fortæller han.
Morten Kornbech Larsen er uddannet kemiingeniør fra DTU og har selv designet flowet i den nuværende
Fra venstre mod højre ses: Emil Fossdahl HechtNielsen, Emil Lynge Rasmussen, Stefan Perovic, Agnete Terkelsen, Bagsværd Lakrids’ direktør Morten Kornbech Larsen og Amanda Rosgaard.
minifabrik. Han har løbende givet de studerende feedback på deres forslag, så de undervejs har kunnet forbedre og justere på det, indtil de officielt præsenterede forslaget i foråret 2023 foran bl.a. repræsentanter fra Gladsaxe Kommune og den samlede ledelse i Bagsværd Lakrids.
Efter den officielle præsentation har Morten Kornbech Larsen valgt at ansætte de fem studerende i en kortere periode, så de har kunnet videreudvikle deres bud på indretningen i samarbejde med Morten Kornbech Larsen. Planen er, at en ny indretning skal realiseres i løbet af efteråret 2023. 1
4 Læs mere på www.bagsvaerdlakrids.dk
DTU DYNAMO NR. 74 09 2023 37
”De studerende udfordrer mit perspektiv, fordi de i modsætning til mig ser på arbejdsgangene i vores fabrik med helt nye øjne, og samtidig har de tid til at lave en langt grundigere analyse, end jeg har.”
DIREKTØR
MORTEN KORNBECH LARSEN, BAGSVÆRD LAKRIDS
Fælles brainstorm i lakridsfabrikken
Lærke Tang Münsberg, der læser til produktionsingeniør på DTU, bruger sine kompetencer inden for idéudvikling til at skabe nye produkter hos Bagsværd Lakrids i samarbejde med ledelsen.
N år Lærke Tang Münsberg ikke bruger tid på sit diplomingeniørstudie på DTU, befinder hun sig to gange om ugen blandt enorme gryder og store stålfade fyldt med skoldhed lakridsmasse i Bagsværd Lakrids’ minifabrik på Bagsværd Hovedgade. Her udvikler den 21-årige DTU-studerende nye produkter i samarbejde med virksomhedens direktør, Morten Kornbech Larsen.
P.t. er Lærke Tang Münsberg i gang med at skabe en lakridscreme, der skal gå perfekt sammen med en portion is.
Udfordringen ligger i at finde den rigtige konsistens og smag, som først opstår, når lakridscremen blander sig
Münsberg læser til daglig til produktionsingeniør på DTU og arbejder i sin fritid hos Bagsværd Lakrids, hvor hun hjælper med at udvikle en lakridscreme.
med isen. Når hun og Morten Kornbech Larsen bliver tilfredse med resultatet, vil lakridscremen være klar til at blive solgt i den lille butik, som også er en del af Bagsværd Lakrids’ fabrik, samt i de 750 forhandlere, der i dag fører Bagsværd Lakrids.
Fra student til medudvikler
Lærke Tang Münsberg startede hos Bagsværd Lakrids i 2020, da hun som nybagt student var på jagt efter et fuldtidsarbejde, inden hun skulle et halvt år på højskole og bagefter begynde på DTU.
”Jeg startede helt fra bunden med at pakke lakrids, så blev jeg oplært som lakridsmager, og i dag er jeg med til at skabe nye produkter og kan kalde mig for medudvikler,” fortæller hun.
For Lærke Tang Münsberg er jobbet som medudvikler et godt og lærerigt supplement til hendes studie på DTU.
”Som medudvikler dykker jeg langt mere ned i detaljer i en produktion, end hvad jeg gør på mit studie. Der er det nemlig de store rammer for en produktion, som er i fokus. Kombinationen af de to er derfor helt perfekt,” forklarer hun.

Når Lærke Tang Münsberg er færdiguddannet produktionsingeniør, kan hun styre og udvikle virksomheders produktionskæder – lige fra valget af leverandører til introduktionen af nye, digitale produktionsformer.
Som produktionsingeniør kan hun også være med til at skabe en mere konkurrencedygtig, ansvarlig og bæredygtig produktion ved at udvikle og optimere virksomheders processer og arbejdsgange.
38 SAMARBEJDE
1
2 Linnea Lundberg
3 Magnus Møller
Lærke Tang
Bæredygtig osteproduktion
Forskere fra DTU Fødevareinstituttet er lykkedes med at udvikle en ostekultur, der kan reducere lagringstiden på lagret Danbo-ost til kun 13 uger. En ost skal typisk lagres mellem et par uger og op til mere end et år for at opnå den ønskede smag og aroma.
En ostekultur har til opgave at producere mælkesyre samt modningsenzymer. Modningsenzymerne findes inde i mælkesyrebakterierne og bliver normalt frigivet langsomt i løbet af ostemodningsperioden. Problemet med eksisterende løsninger er, at denne proces foregår langsomt og kun delvist. Men DTU’s nye kultur frigiver alle modningsenzymer på en gang, hvilket giver en hurtigere modning.

Modning af oste sker på særlige ostelagre med bestemte krav til temperatur og luftfugtighed. Der er store udgifter forbundet med at lagerbinde ostene i lange perioder. Hvis lagringstiden kan gøres kortere, er der store økonomiske og miljømæssige gevinster at hente.
NYT CENTER SKAL FORSKE I HAVSTIGNINGER
Med en bevilling på 37 mio. kr. fra Novo Nordisk Fonden oprettes Center for Ice-sheet and Sealevel Predictions, der bliver forankret på DTU med professor Shfaqat Abbas Khan i spidsen.

Professoren skal i samarbejde med bl.a. De Nationale Geologiske Undersøgelser for Danmark og Grønland (GEUS), Københavns Universitet og Darthmouth College bl.a. udvikle nye og mere præcise modeller for afsmeltningen af de arktiske iskapper.
FRA DERES VIDENSKABELIGE PUBLIKATIONER.
Udtalt af astronaut Andreas Mogensen, da han i sommer blev udnævnt til adjungeret professor på DTU.

”Rumfart er et utroligt spændende felt, der er i rivende udvikling. Jeg glæder mig til at bakke op om det arbejde, DTU laver, både når det gælder undervisning og forskning.”
DTU’S PLACERING I NORDEN PÅ DEN OPDATEREDE RANG LISTE LEIDEN RANKING. LISTEN RANGERER UNIVERSITETER UD
Nr. 1
3
DTU DYNAMO NR. 74 09 2023 39 NYHEDER FORSKNING
Unsplash, Colourbox, ESA
Kvantespring mod smartere kemikaliefremstilling
DTU samarbejder med en af verdens førende virksomheder om at udnytte komplekse matematiske beregninger i form af kvanteinspirerede algoritmer i fremstillingen af kemikalier. Målet er at gøre det hurtigere og billigere at bringe nye kemikalier på markedet og at opnå ny viden, der kan anvendes i fremstillingen af andre produkter.
2 Miriam Meister
Det kan være både tidskrævende og dyrt at opskalere en idé, der er blevet demonstreret i laboratoriet, til også at kunne anvendes i en storskalaproduktion, for selvom processen fungerer fejlfrit i et kontrolleret eksperiment, kan den sjældent overføres direkte til kommerciel skala.
Der vil oftest være behov for omfattende, dyre og tidskrævende eksperimenter for at tilpasse processer og metoder, før man opnår det samme resultat uden for laboratoriet.
”Industrielle procesanlæg opererer på flere niveauer – lidt ligesom vores kroppe. Hvis jeg for eksempel har ondt i hovedet, kan årsagen være en bakterie i tarmen,” forklarer lektor på DTU Seyed Soheil Mansouri og fortsætter:
”I stedet for at skulle udføre eksperiment efter eksperiment efter eksperiment og fejle og fejle og fejle, fordi man ikke går strategisk til problemet, så har vi en mere avanceret tilgang,” forklarer Seyed Soheil Mansouri.
Om kvanteinspirerede algoritmer
Kvanteinspirerede algoritmer er baseret på matematik, som fysikere har introduceret for at kunne simulere komplekse kvantesystemer. De involverer ofte meget komplekse konstruktioner, der effektivt kan repræsentere sammenhænge mellem variable.
I modsætning til egentlige kvantealgoritmer, så kan kvanteinspirerede algoritmer køre på almindelige computere. De kan dog også tilpasses, så de kan køre på fremtidens kvantecomputere, hvilket vil fremskynde sammenkoblingen mellem high-performance computing og kvantecomputere.
”Konceptet er det samme inden for biotekindustrien. Når vi støder på et problem i processen, findes løsningen muligvis et helt andet sted. Så vi har brug for at få indblik i, hvordan disse forskellige niveauer – helt fra molekylær- eller atomarskala til produktionsskala – interagerer med og påvirker hinanden.”
Færre unødvendige eksperimenter
DTU råder over et avanceret pilotanlæg, som bruges til at gøre idéer, der involverer kemiske og biologiske processer, til kommerciel virkelighed.
I pilotanlægget kan brugerne teste, validere og kvalificere strategier, indtil problemerne er løst, og idéen er klar til kommerciel brug.
For at undgå unødvendige tests benytter brugerne modellering til at pejle sig nærmere ind på de områder, der sandsynligvis er skyld i problemerne.
I et nyt projekt vil DTU-forskere samarbejde med de amerikanske AIeksperter Zapata Computing om at undersøge, hvordan brugen af kvanteinspirerede algoritmer (se forklaring i boksen) kan bringe en idé på markedet billigere og hurtigere ved effektivt at lokalisere de mulige problemområder og dermed undgå for mange unødvendige eksperimenter.
”Ved at kombinere vores viden om kemiske og biologiske processer med Zapatas ekspertise inden for avancerede computerberegninger sigter vi mod at udvikle mere avancerede algoritmer, der kan tackle de problemer, vi ikke kan tackle i dag,” siger Seyed Soheil Mansouri.
En revolutionerende tilgang Zapata Computing er opkaldt efter manden, der startede den mexicanske revolution i starten af sidste århundrede – og når man lytter til CEO Christopher Savoie, fornemmer man straks, at hans virksomhed deler Zapatas iver efter at skabe radikale forandringer:
”De fleste administrerende direktører for en teknologivirksomhed vil sige, at deres teknologi kommer til
Pilot Plant på DTU Kemiteknik bruges af forskere, studerende og virksomheder til at teste, om deres idéer kan skaleres op og blive kommercielt levedygtige.
DYNAMO NR. 74 09 2023 40 OPTIMERING
3 Jørgen True
at forandre verden. Og det er, uanset om de sælger en datingapp eller noget andet. Derfor gør det faktisk også lidt ondt at sige disse ord højt, men jeg tror rent faktisk på, at det her vil føre til håndgribelige og væsentlige forandringer på områder, der betyder noget for os.”
Man behøver ikke at have en kvantecomputer for at arbejde med kvanteinspirerede algoritmer. De algoritmer, som partnerskabet sigter mod at udvikle, har imidlertid potentiale til at kunne overføres til kvantecomputere, når og i takt med at de bliver tilgængelige.
”Vores tilgang i det her projekt giver os nogle fordele her og nu, som gør det muligt at foretage flere beregninger på kortere tid,” forklarer Christopher Savoie.
I projektet vil partnerne arbejde baglæns i den forstand, at de tager problemer, der allerede er løst på konventionel vis, og tester, om kvantetilgangen giver en fordel ved at gøre opskaleringsprocessen hurtigere og billigere eller ved at reducere de omkostninger, der er forbundet med eksperimenterne.
”Vi vil anse det som en succes, hvis vi kan finde ét problem, hvor vi kan lykkes med at demonstrere, at vi ved hjælp af kvanteinspirerede algoritmer kan sætte yderligere skub i mulighederne for at producere biomolekyler i stor skala. Det ville være beviset på, at vi er på rette vej,” siger Seyed Soheil Mansouri. 1


DTU 41
5 Seyed Soheil Mansouri, lektor, DTU, seso@kt.dtu.dk
”Industrielle procesanlæg opererer på flere niveauer – lidt ligesom vores kroppe. Hvis jeg for eksempel har ondt i hovedet, kan årsagen være en bakterie i tarmen.”
LEKTOR SEYED SOHEIL MANSOURI, DTU
EN LIDT GRØNNERE OG SJOVERE ROSKILDE FESTIVAL
Studerende fra DTU tog 15 projekter med på Roskilde Festival denne sommer for at teste deres idéer til en festival, der tager højde for både bæredygtighed, sikkerhed og sundhed. Her er nogle af projekterne.


Fald foran scenen kan forebygges
Adrian Valentin og Christoffer Wejendorp studerer begge kunstig intelligens på DTU og afprøver et computersystem, der kan detektere personer, der har problemer med balancen. Hvis de spottes i publikum, kan de få hjælp, og på den måde er det muligt at forebygge fald til koncerter. I computersystemet indgår et kamera og en algoritme, som de to studerende tester brugen af.
Luftmadras af stilladspresenninger
Seks diplomingeniørstuderende har udviklet en luftmadras, der løser det affaldsproblem i stilladsbranchen, som stilladspresenninger udgør. For presenningerne kan ikke genbruges af branchen selv. I stedet kan plastikken udnyttes til luftmadrasser, som de studerende har syet og svejset nogle prototyper af. På årets festival blev madrasserne testet for at se, hvor længe de kunne holde luft, ligesom der blev gennemført spørgeskemaundersøgelser hos forsøgsbrugerne af madrassen.
DYNAMO NR. 74 09 2023 42 ET LEVENDE LABORATORIUM
2 Katrine Krogh-Jeppesen og Henriette Stentebjerg
3 Ditte Valente
Ørepropper af svampe
Silja, Jade og Seval har udviklet en prototype på ørepropper lavet af biomasse fra østerssvampen. Ørepropper er efterspurgte til koncerter for at forebygge høreskader. Normalt laves de af plastik.



”Problemet med de nuværende festivalørepropper er, at de let bliver tabt eller glemt. De bidrager derefter til affaldscyklussen gennem forurening af fællesarealer og til sidst vores økosystem,” siger Silja.
Plastik kan tage over 50 år at nedbryde, mens svampebiomasse nedbrydes på dage.
Materialet til ørepropperne blev dyrket af lokalt fremstillede danske svampe i foråret 2023 på DTU, hvor der også var støtte til akustikprøvning.
”Hvis reaktionerne er positive, overvejer vi at fortsætte udviklingen efter festivalen. Måske har vi færdige ørepropper, som vi kan teste næste år,” siger Seval.
En cykeltur, der oplader mobiltelefonen

Motion er måske ikke den mest prioriterede beskæftigelse på en festival. Men hvis det kan kombineres med et vigtigere behov, nemlig en fuldt opladet mobiltelefon, så kan det måske få nogle til at få pulsen op. Med en motionscykel koblet til et større batteri var det muligt for festivalgængere at cykle sig til en opladning af mobiltelefonen. Og strømmen var 100 pct. grøn!

FÅ DYNAMO TIL DØREN – HELT GRATIS
Hvis du ikke allerede er abonnent på Dynamo, eller hvis du kender nogen, der kunne tænke sig at få magasinet tilsendt, så husk, at det er ganske gratis.


Send en mail med navn og arbejdseller privatadresse til dynamo@dtu.dk. Så lander magasinet i din postkasse eller på dit skrivebord fire gange om året.





AFGRØDERNE Ny detektor afslører både supernovaer og brystkræft Hvad er absolut bæredygtighed? SÅDAN SKABER VI ENERGIØER Teknologiudvikling af el-infrastruktur, havvindmøller og Power-to-X skal bane vejen til øernes succes. TEMA BIOTEKNOLOGI Grøn omstilling med hjælp fra mikroberne GODT NYT OM Kvindelige iværksættere mødes med skepsis Får vi brugt overskudsvarmen fra datacentrene? KVANTETEKNOLOGI TEMA De første løsninger er udviklet og bliver testet HVAD MOZZARELLA KAN LÆRE OS OM MATERIALER Plaster med sensor hjælper psykiatrien Hvad er ansvarlig teknologi? DTU-PROJEKTER EN PERFEKT STORM … fører til mangelsamfundet TEMA UDNYTTELSE AF RESTBIOMASSE Skosål med silkesensor optimerer cykeltræningen Hvorfor er danskerne dårligst til at mindske kødforbruget? GØR EN FORSKEL PÅ NATURGAS MED EL Ny rekord dataoverførsel Er Danmark klar til havstigninger? NOVO NORDISK OPTIMERER CYBERSIKKERHED TEMA – Nye løsninger, der mindsker angreb
Skriv til dynamo@dtu.dk – og få Dynamo
DTU 43 DTU
tilsendt.
”Samarbejdet med DTU er dannet på baggrund af vores fælles værdier: At give unge mennesker en stemme, et rum til at udvikle sig og modet til at engagere sig i verden.”
FORSKERE SKANNER JERNALDEREN Fra sukker til plastik Hvorfor er der modstand mod vindmøller? ASTEROIDE SKAL TEMA FORSKNING, DER FREMMER SUNDHEDEN Sådan kan bioteknologi hjælpe kampen mod alvorlige sygdomme
CHRISTINA BILDE, VICEDIREKTØR FOR ROSKILDE FESTIVAL
Plastik af sukker
På fotoet ses granulater af PET-plastik, som er fremstillet ved hjælp af en ny metode baseret på nedbrydning af sukkermolekyler udvundet fra biomasse. Ved at erstatte fossil olie med biomasse i plastproduktionen er det muligt at nedbringe plastikkens klimaaftryk. DTU har gennem flere år samarbejdet med virksomheden Topsoe om at udvikle denne nye og mere effektive metode til at udnytte biomasse i plastikproduktionen. PET-plastik er en af de mest anvendte typer af plastik i europæisk emballageindustri.
Læs mere på side 26

DYNAMO NR. 74 09 2023 3 THOMAS STEEN SØRENSEN ZOOM
























 som teknologien giver os.
som teknologien giver os.